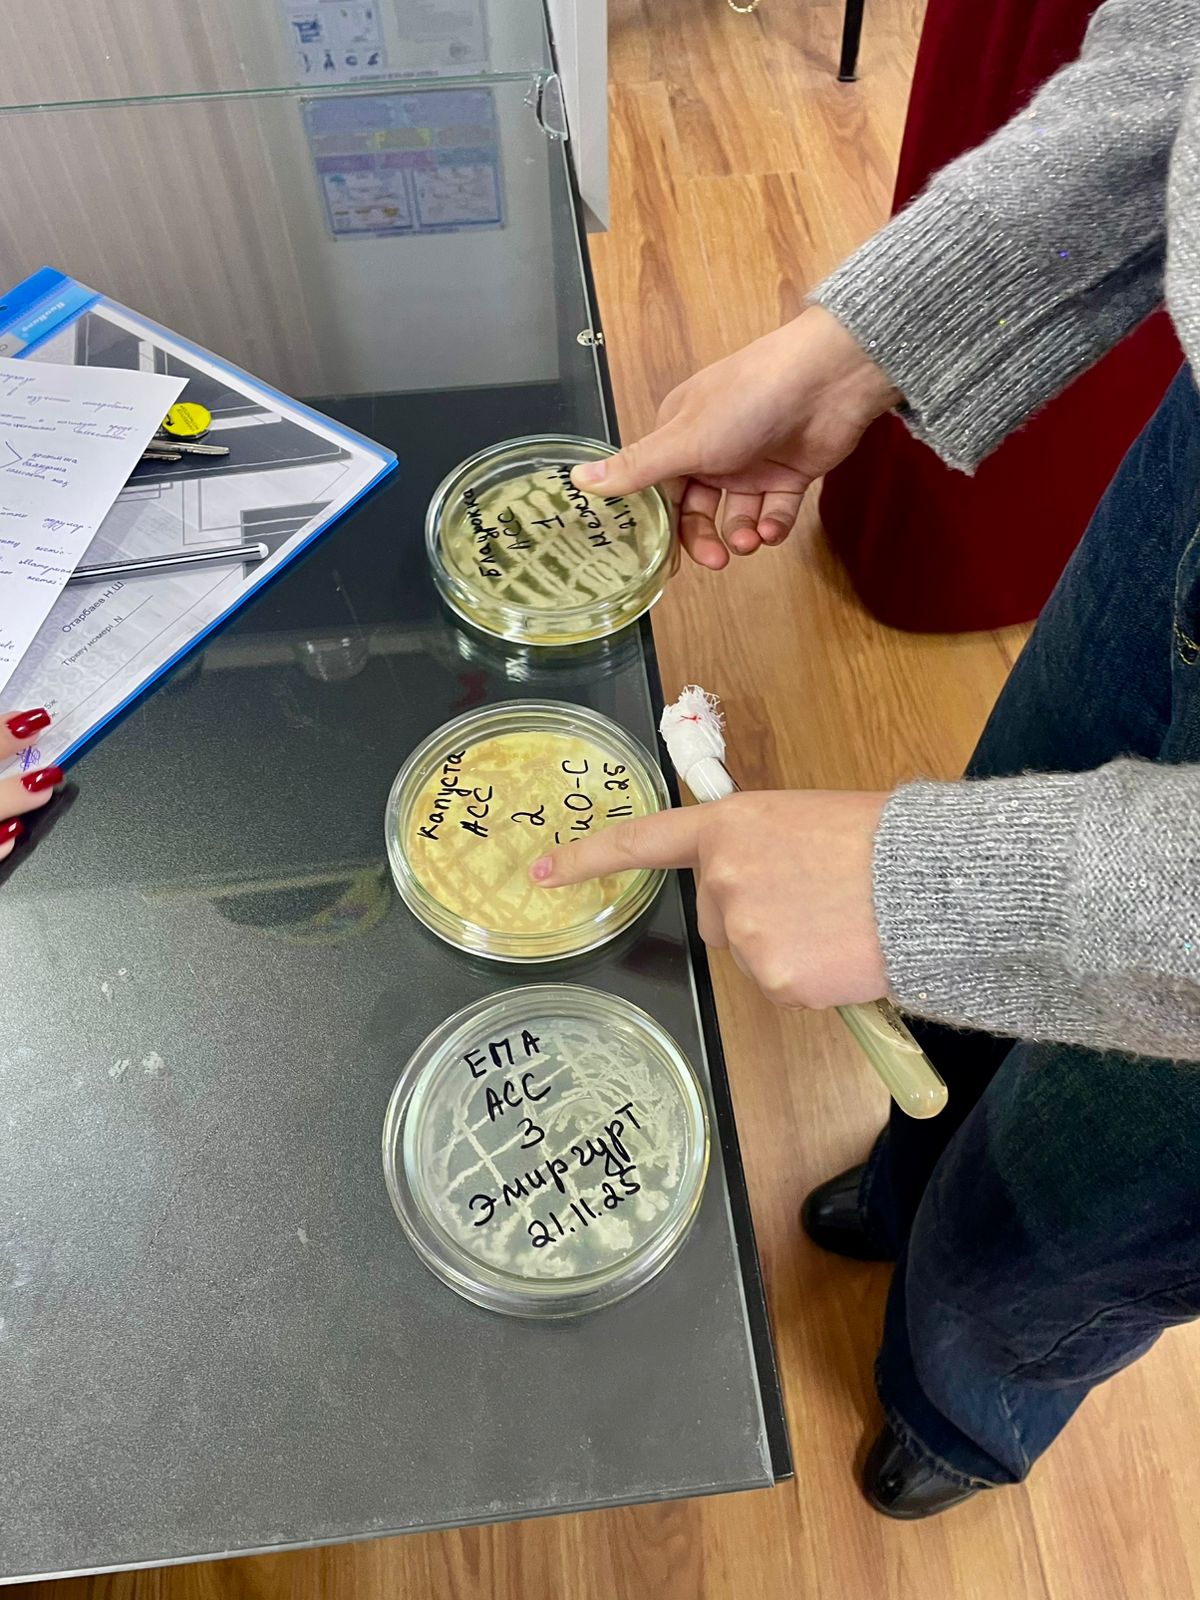
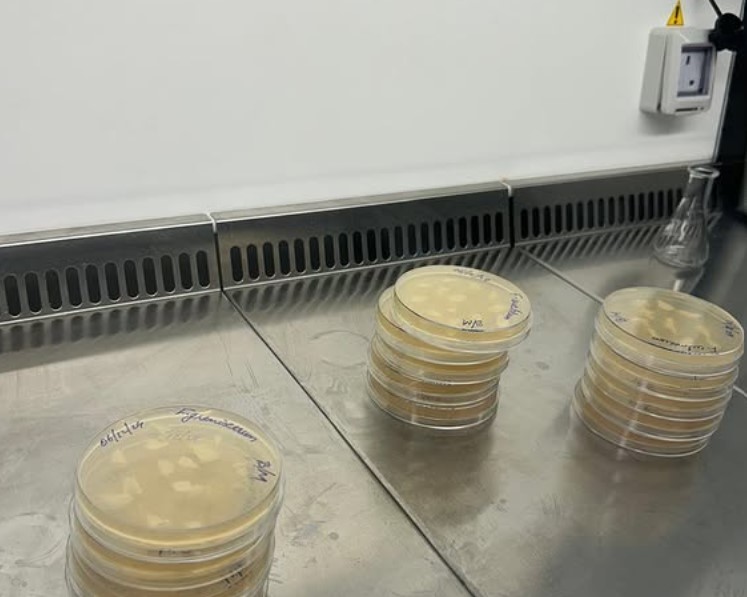
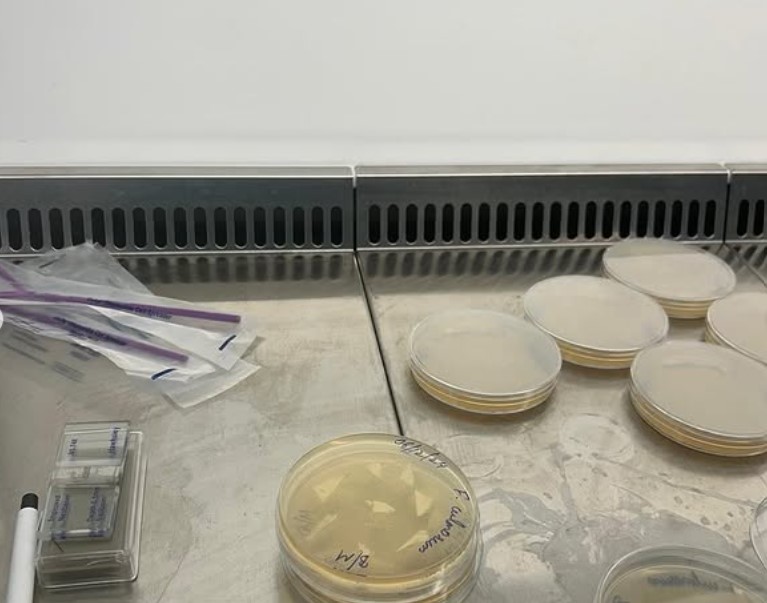
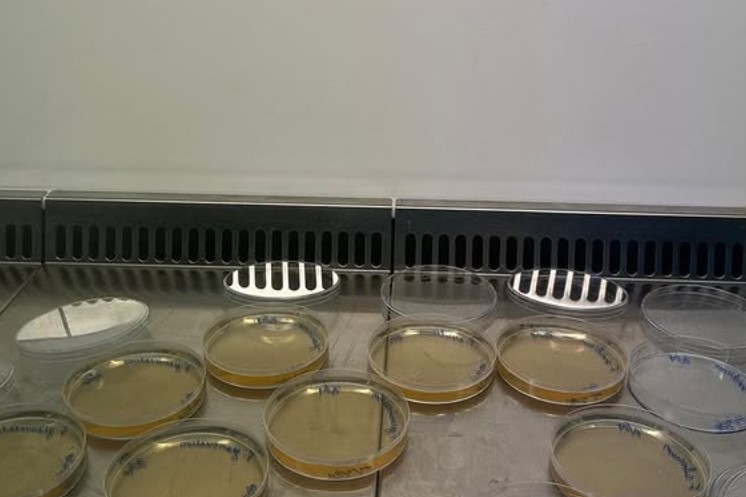
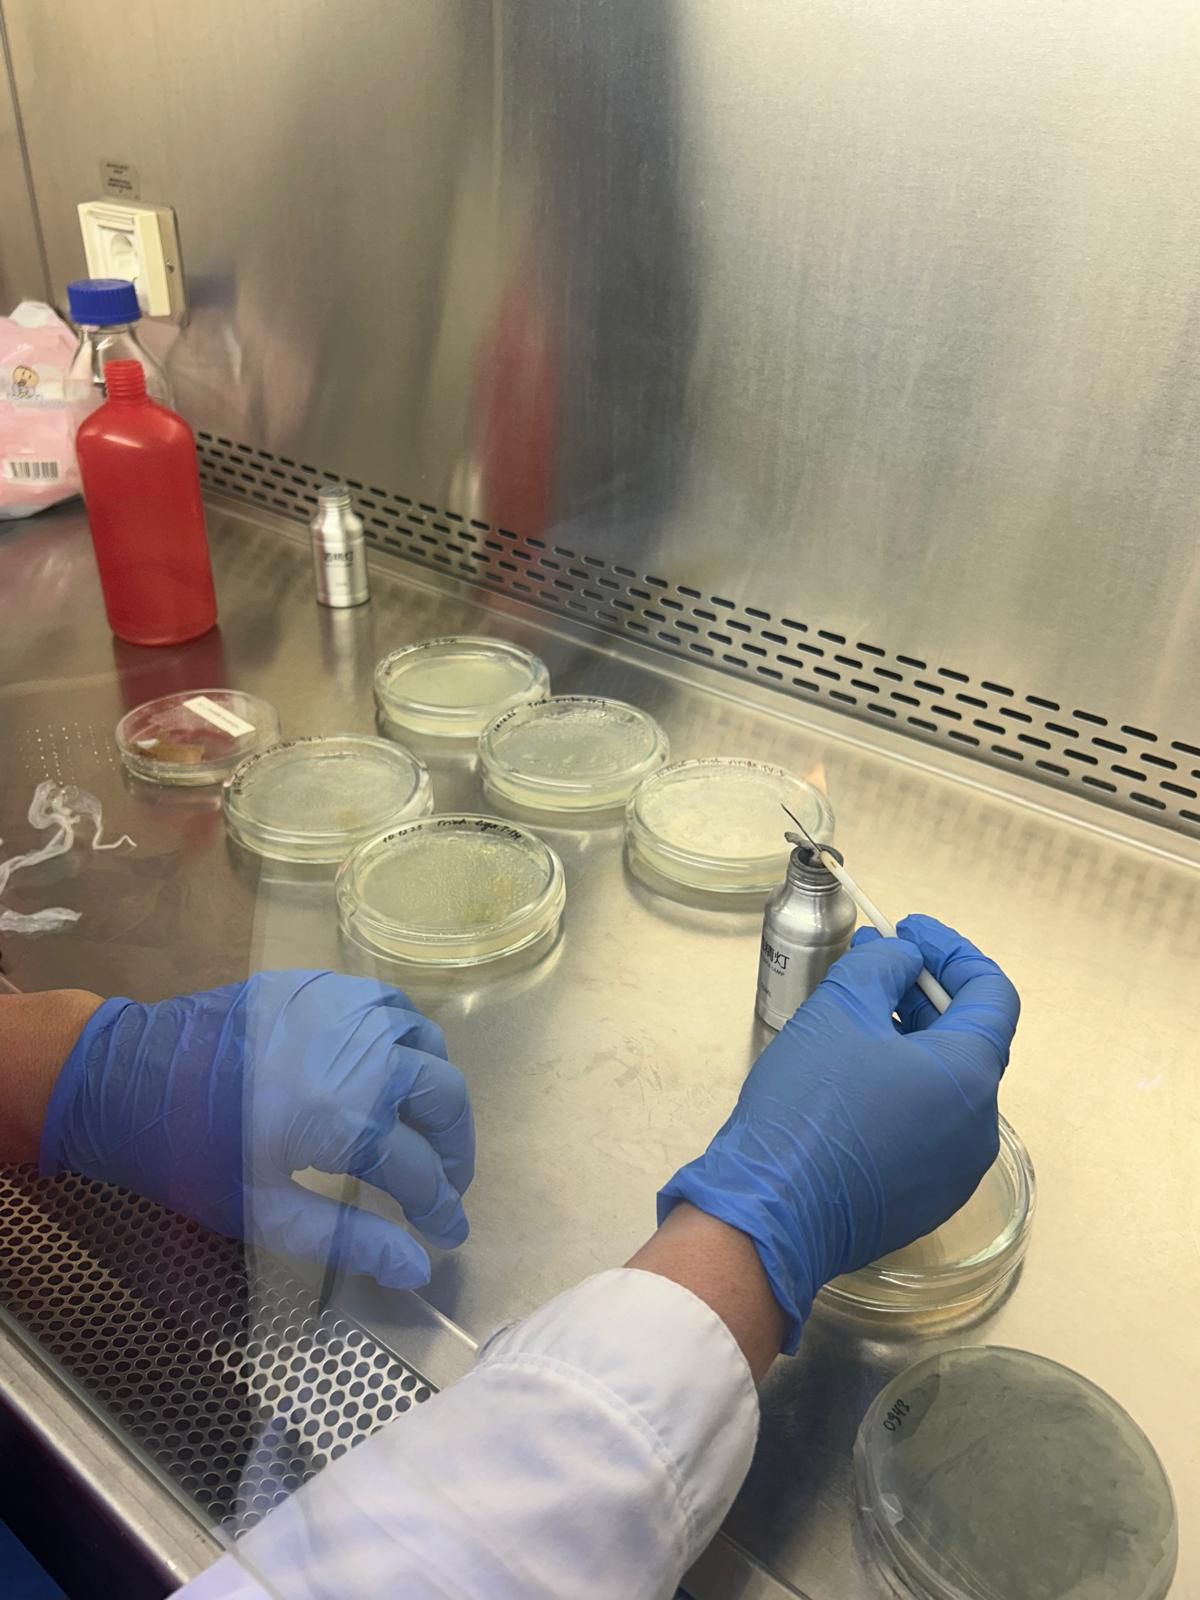
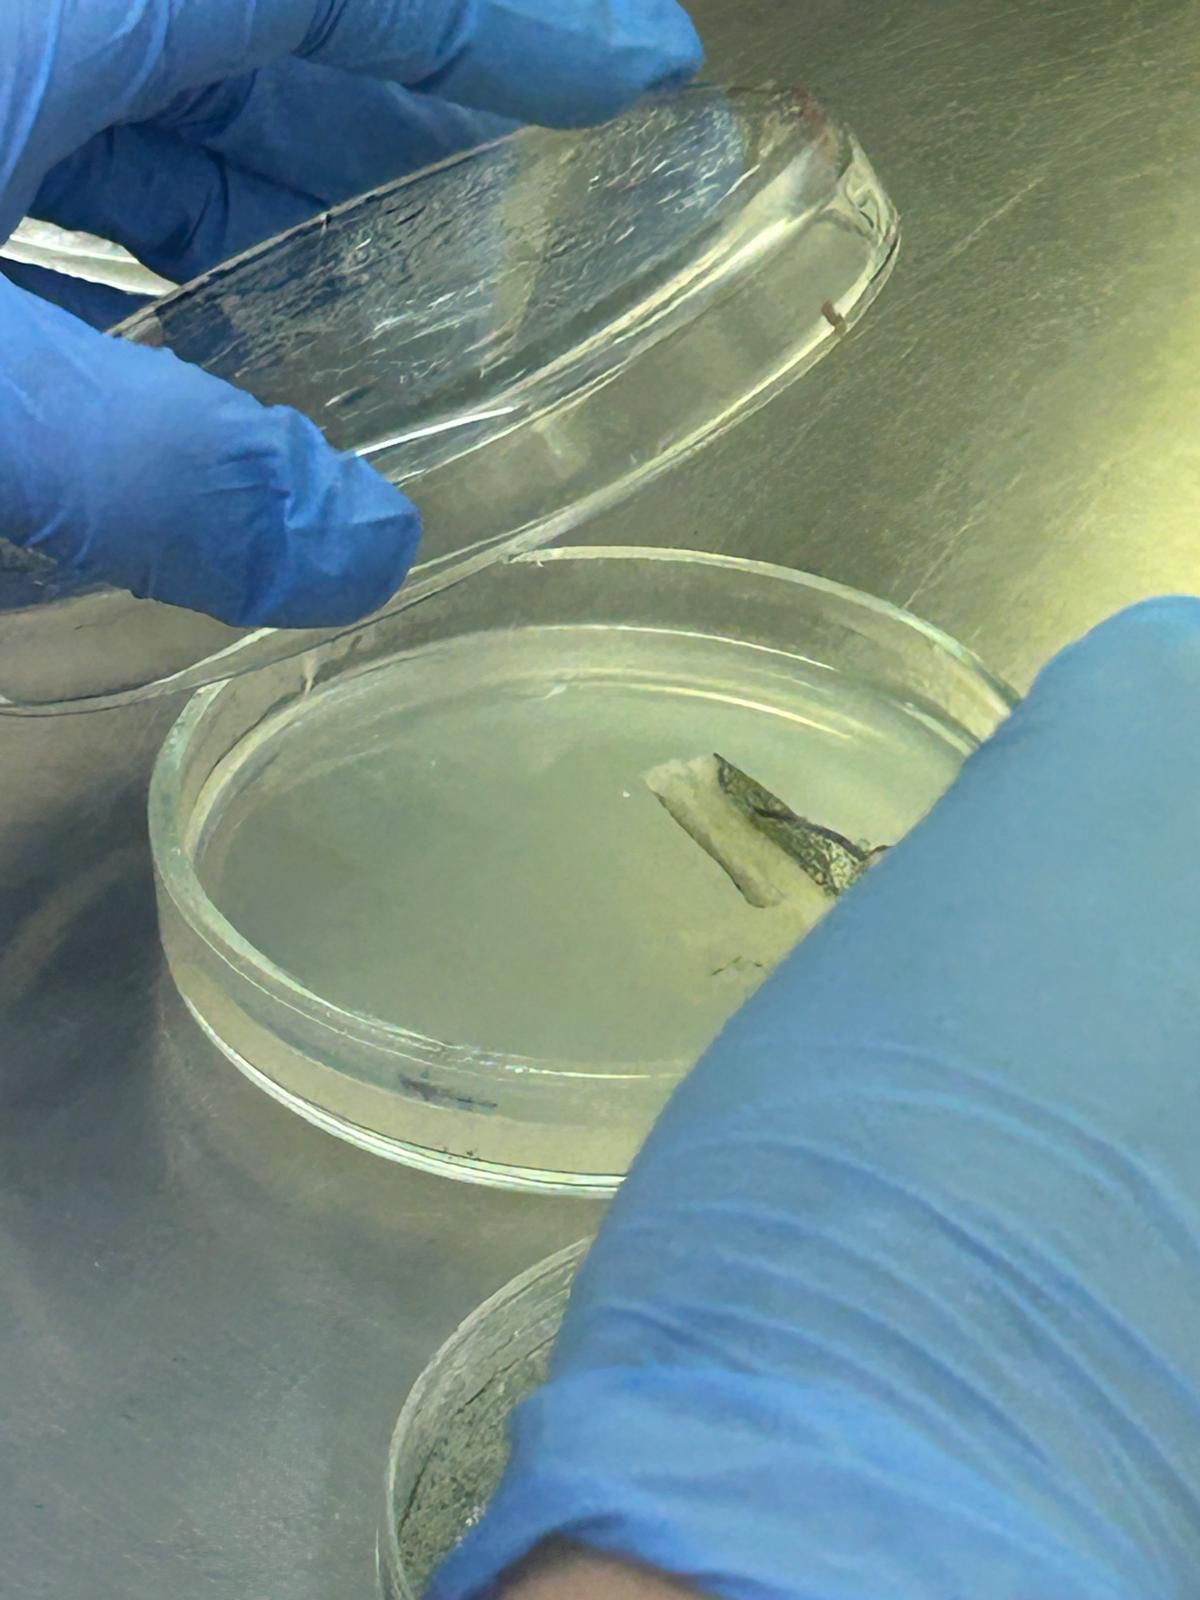
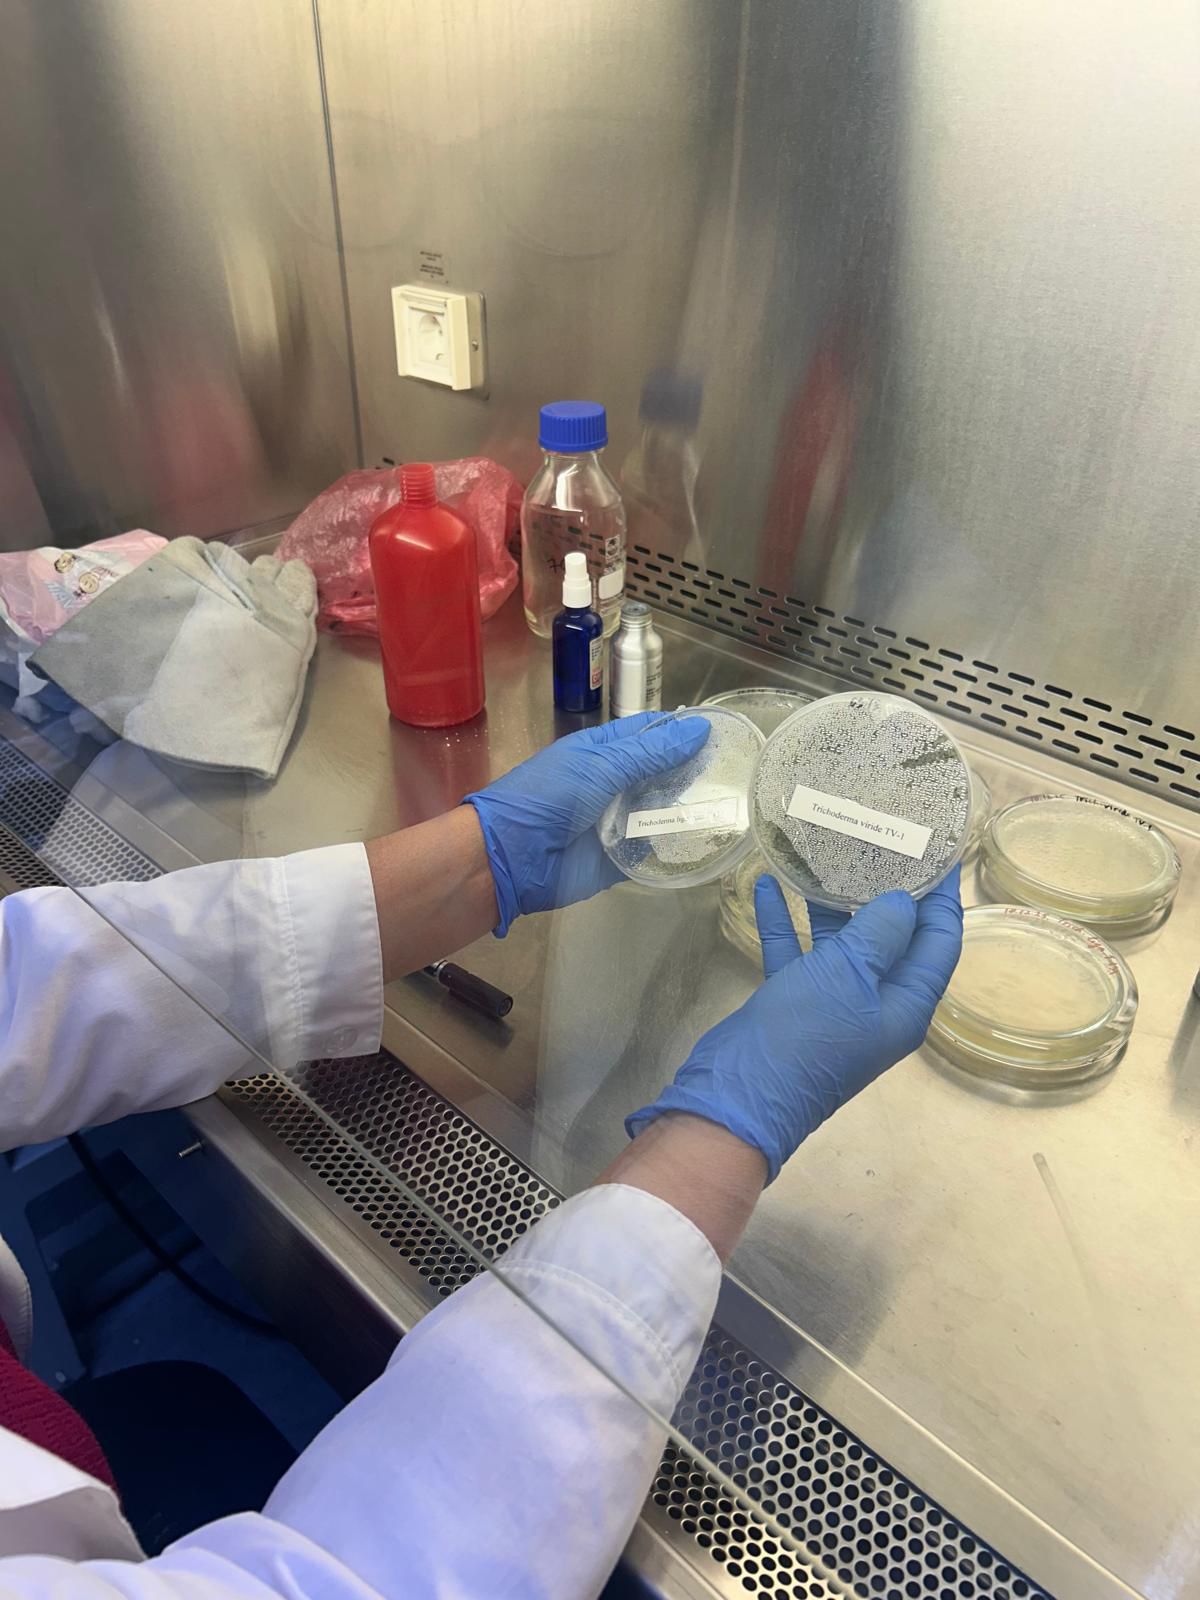
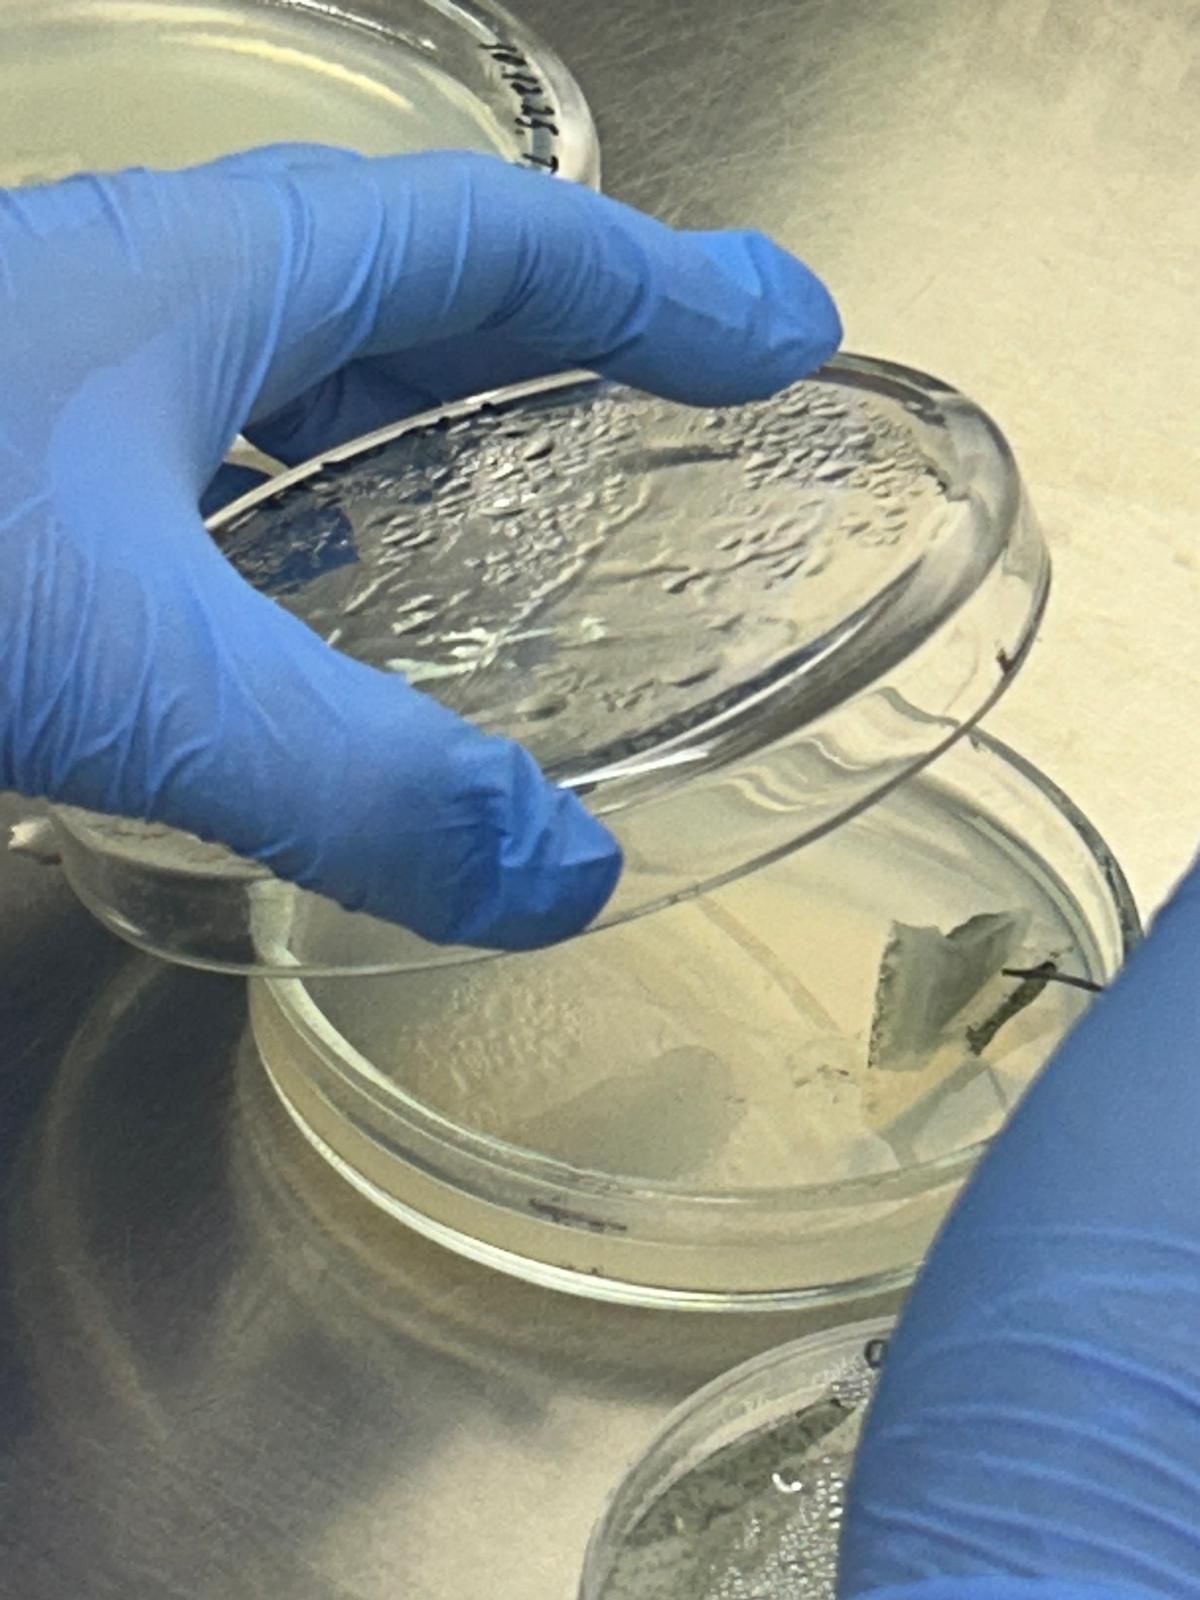
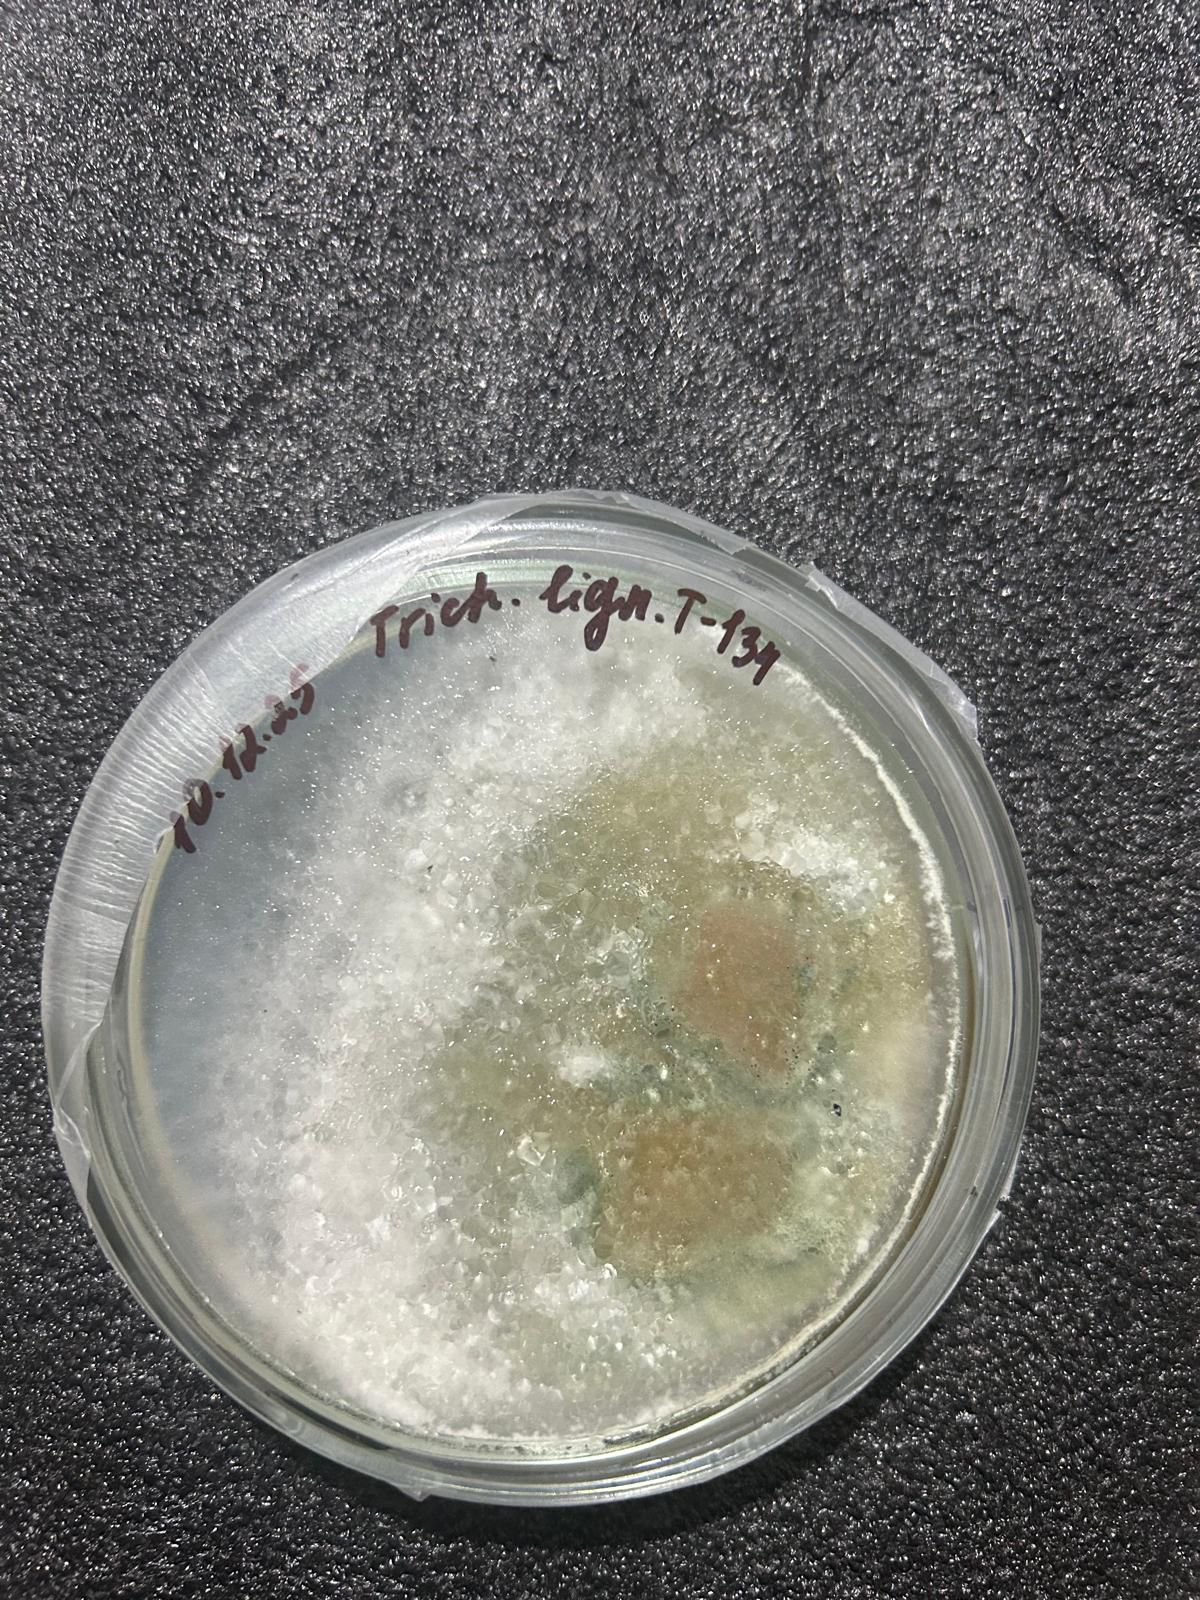
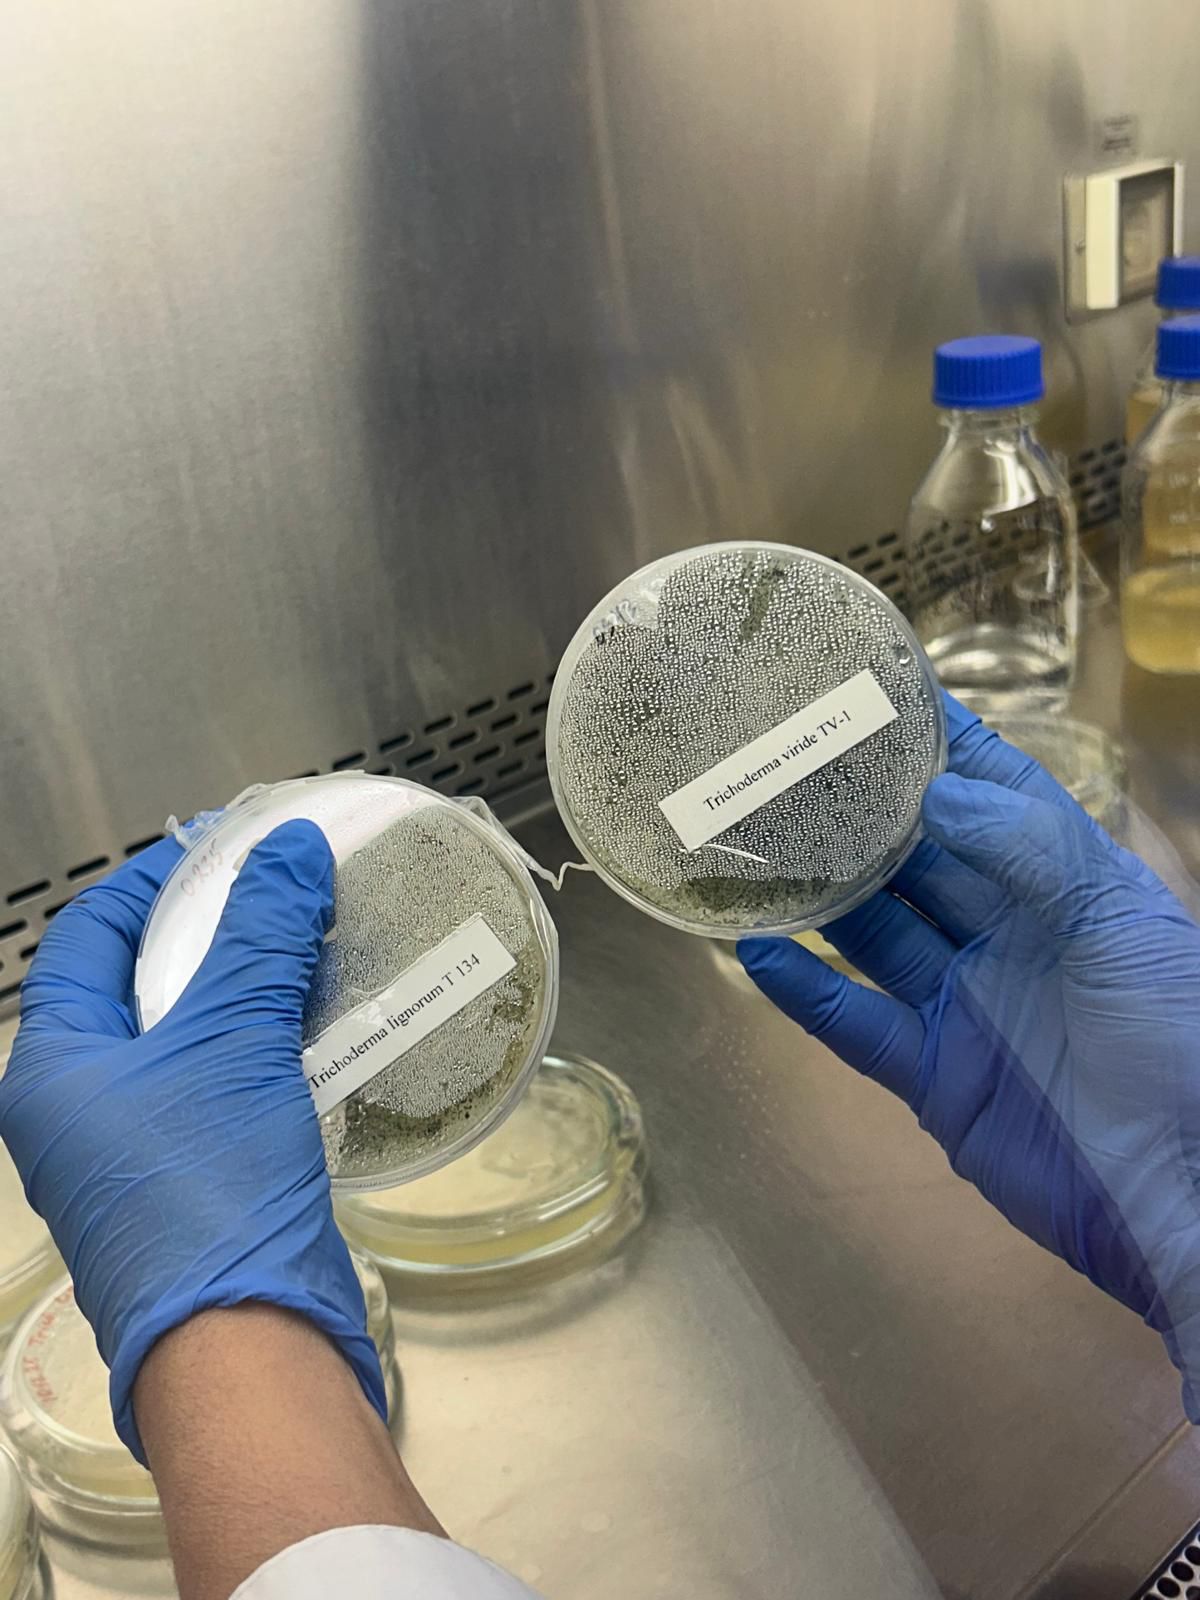
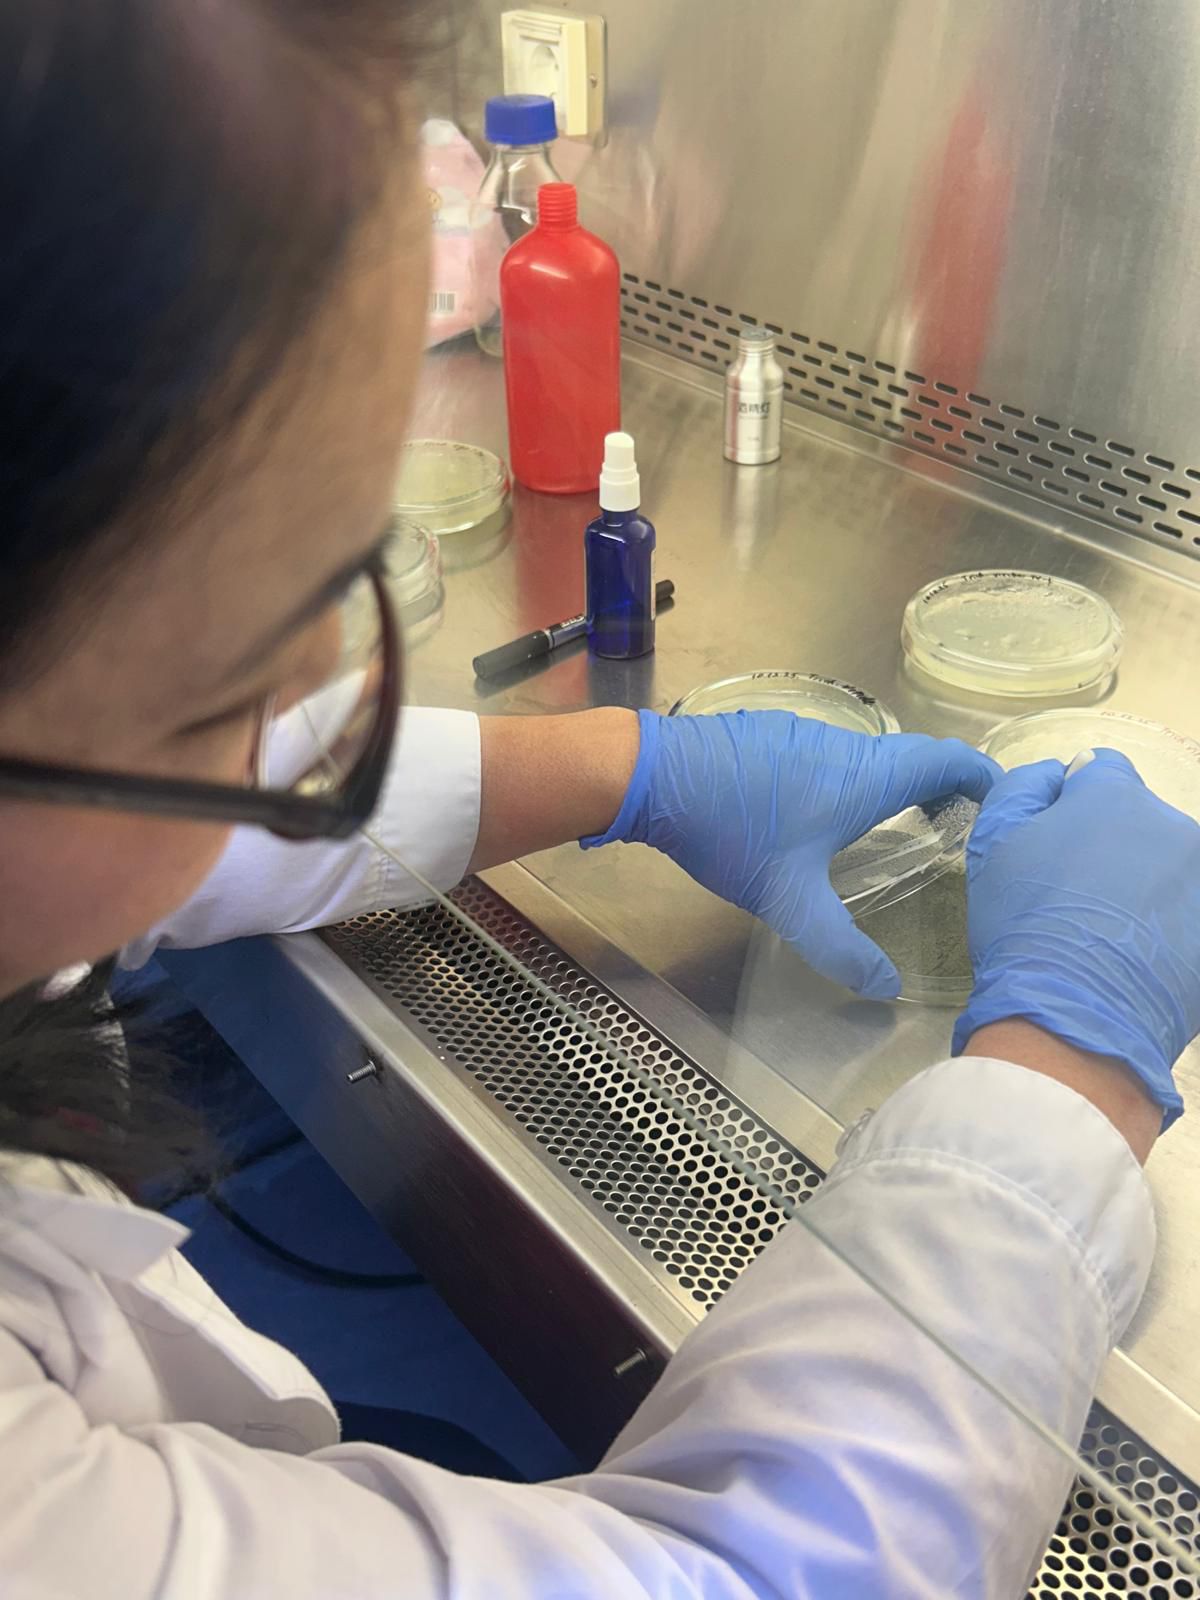
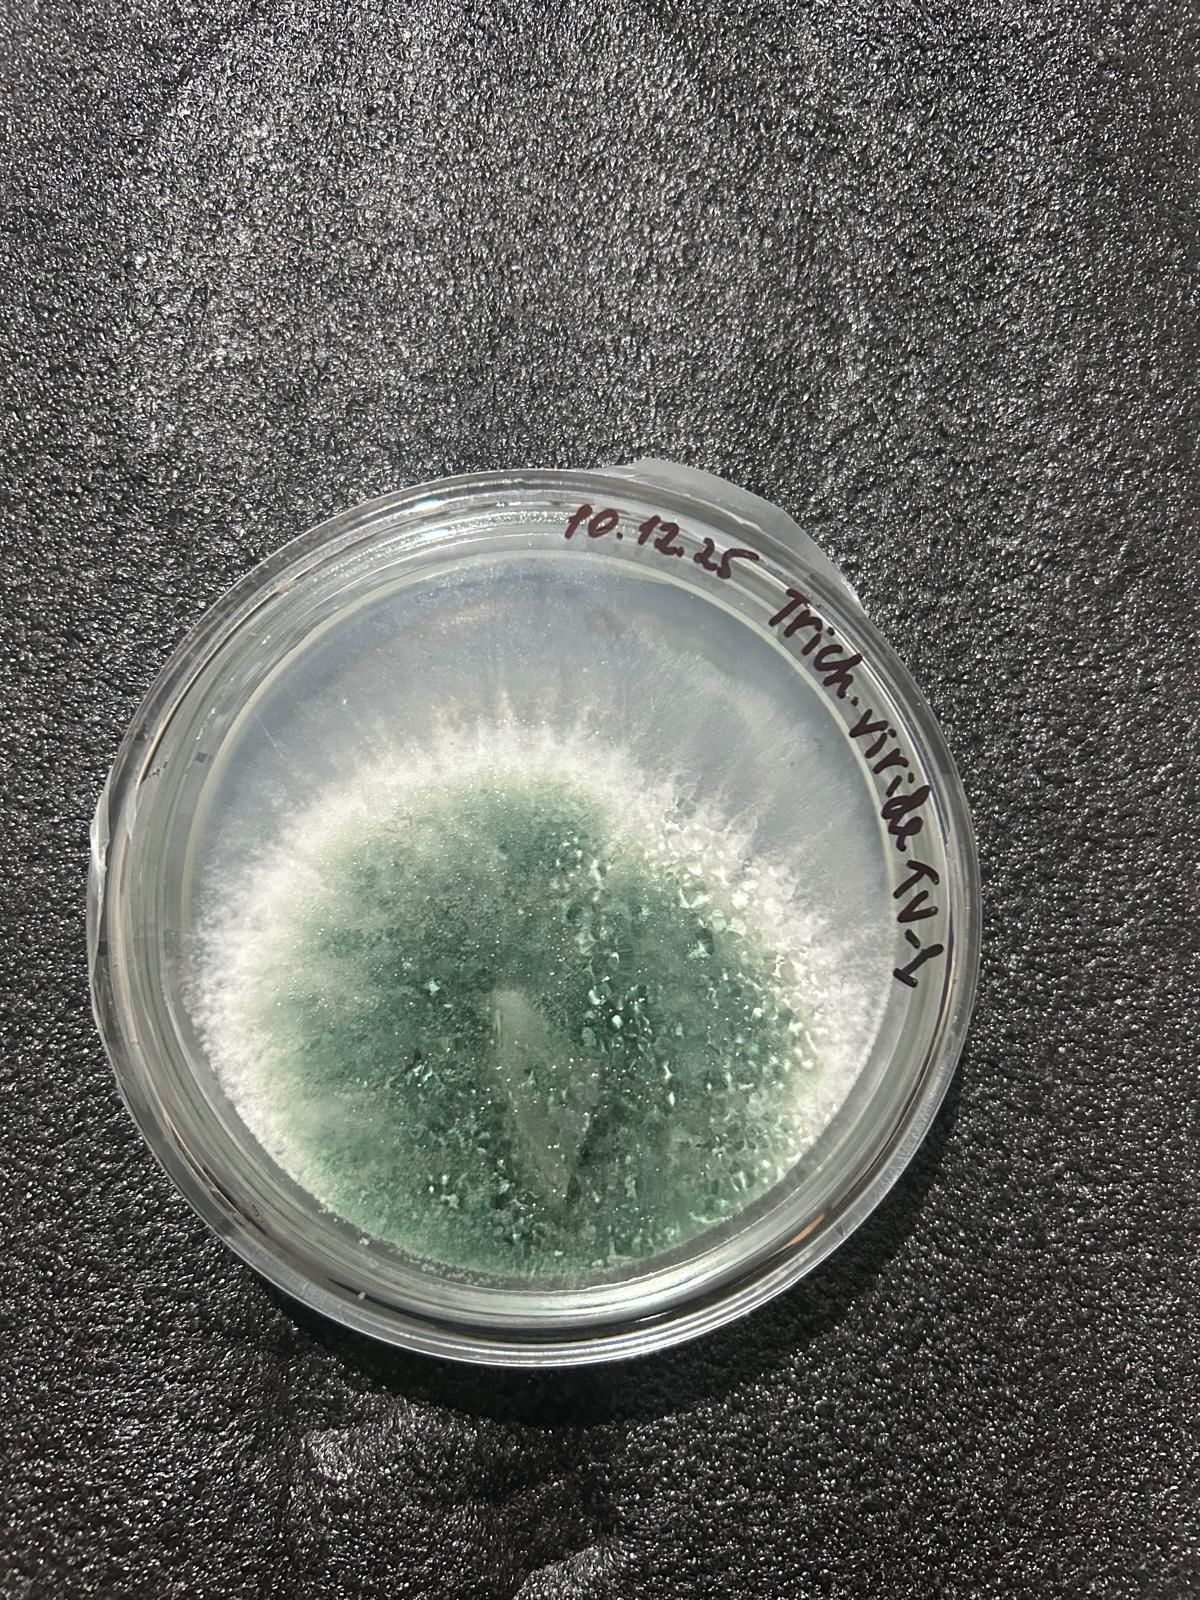
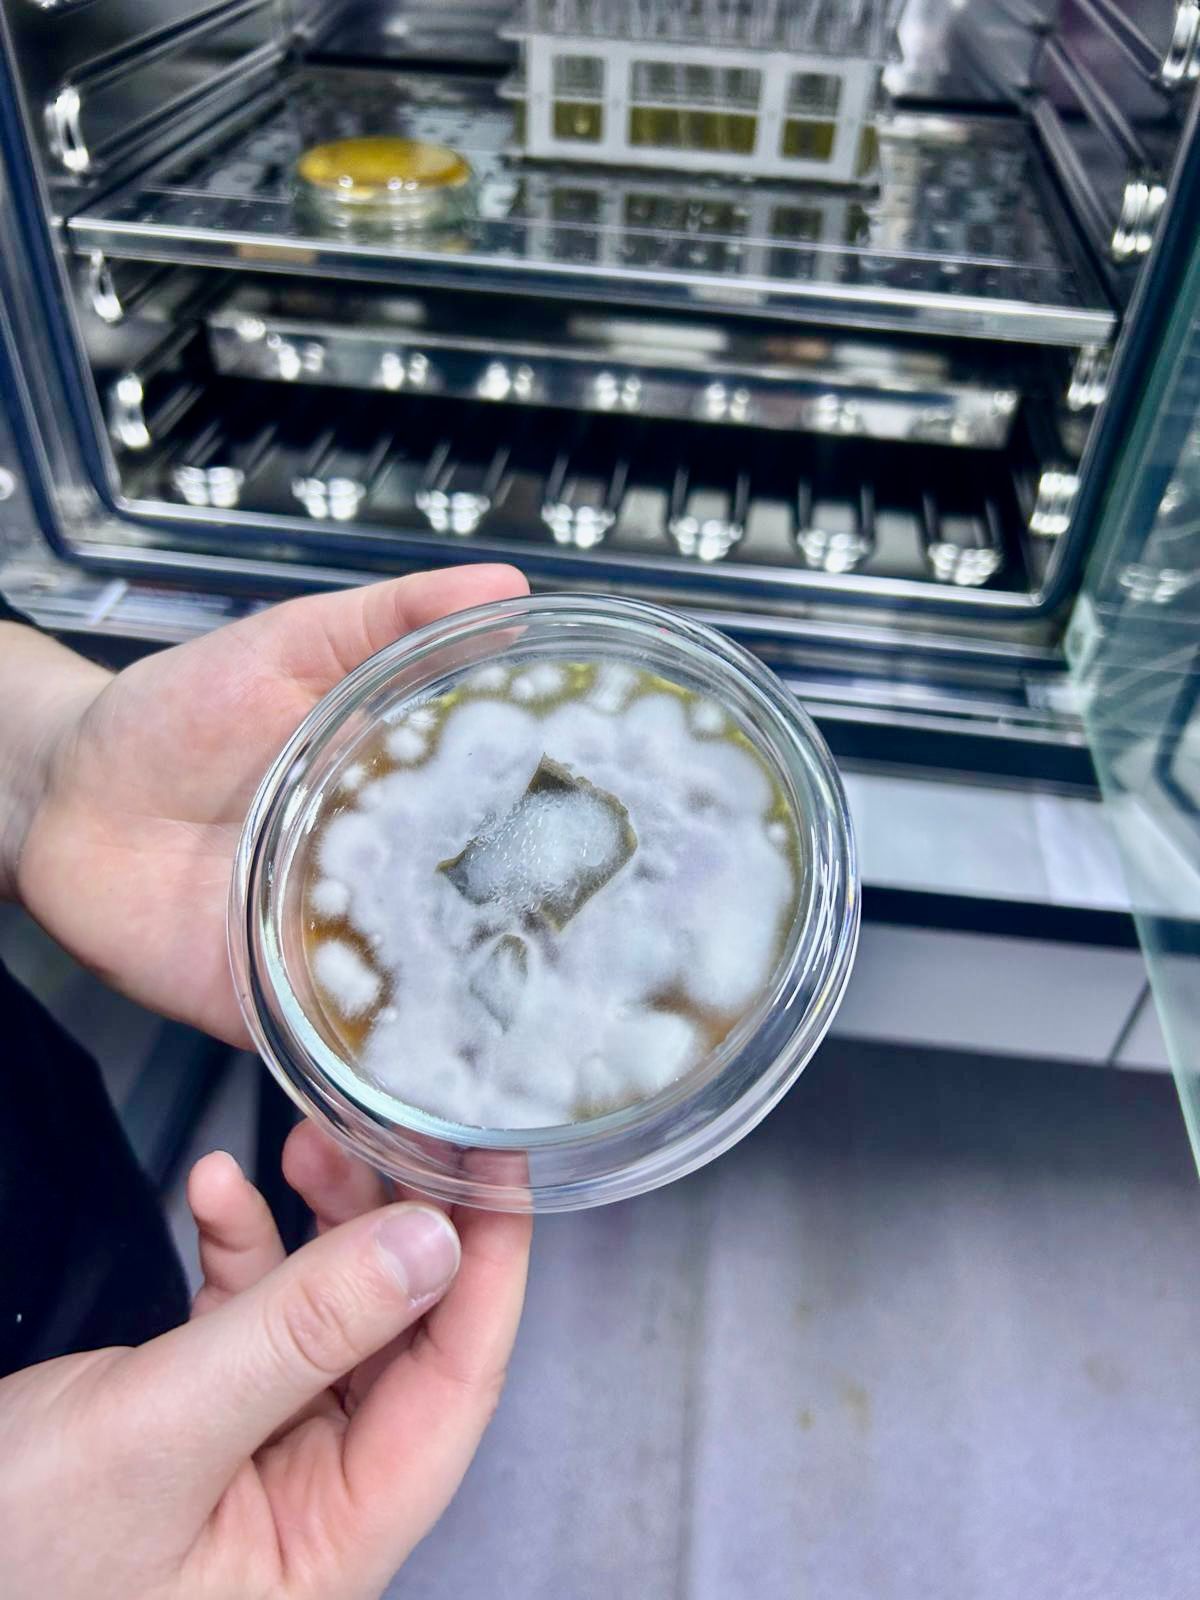

Биотехнология
- Просмотров: 6281

Алпамысова Гулжайна Байгонысовна
Заведующий кафедрой
Кандидат сельскохозяйственных наук, доцент
Адрес: Шымкент, 160050, проспект Тауке хана, 5,
Южно-Казахстанский университет
имени М.Ауэзова, корпус «А»
Телефоны: 8 (7252) 21-19-79, 87052148533
e-mail: Xap68@ mail.ru
Профессорско-преподавательский состав

Алпамысова Гульжайна Байконысовна
Заведующий кафедрой
Кандидат сельскохозяйственных наук, доцент
Контактная информация: Корпус: 1 (А), 215
Рабочий телефон: 8 (7252) 21-19-79, 87712489338
Е-mail: Xap68@ mail.ru

Кедельбаев Бахытжан Шильмирзаевич
Доктор технических наук, профессор
Контактная информация: Корпус: 1 (А), 315
Рабочий телефон: 21 19 71, 87053560362
Е-mail: kedelbaev@ iandex.ru

Алибаев Нуридин Нажмединович
Доктор сельскохозяйственных наук, профессор
Контактная информация: Корпус: 1 (А), 315
Рабочий телефон: 21 19 79, 87017203237
Е-mail: Адрес электронной почты защищен от спам-ботов. Для просмотра адреса в вашем браузере должен быть включен Javascript.

Сапарбекова Альмира Амангельдиевна
кандидат биологических наук, профессор
Контактная информация: Корпус: 1 (А), 224
Рабочий телефон: 8 (7252) 21-19-79 95-32-68, 87054907555
Е-mail: Asaparbekova@ mail.ru

кандидат химических наук, доцент
Контактная информация: Корпус: 1 (А) , 213
Рабочий телефон: 21 19 79 27-35-01, C. 87751961866
Е-mail: Anar.esimova@ mail.ru

Ибраимова Жулдыз Кайратовна
старший преподаватель, доктор PhD
Контактная информация: Корпус: 1 (А) , 217
Рабочий телефон: 21 19 79 27-35-01, C. 87022665664
Е-mail: Адрес электронной почты защищен от спам-ботов. Для просмотра адреса в вашем браузере должен быть включен Javascript.

кандидат сельскохозяйственных наук, доцент
Контактная информация: Корпус: 1 (А), 226
Рабочий телефон: 21 19 79, 87753741211
Е-mail: ahanov@ mail.ru

Рысбаева Гульнара Султанбековна
старший преподаватель
Контактная информация: Корпус: 1 (А), 213
Рабочий телефон: 21 19 79, 87786583308
Е-mail: aikona@mail.ru

Муталиева Ботагоз Жаксылыковна
кандидат химических наук, ассоциированный профессор
Контактная информация: Корпус: 1 (А), 217
Рабочий телефон: 21 19 79, 8-7086956430
Е-mail: Mbota@ list.ru

Даулбай Амина Дуйсенхановна
кандидат сельскохозяйственных наук, доцент старший преподаватель
Контактная информация: Корпус: 1 (А), 217
Рабочий телефон: 21 19 79, 87077407783
Е-mail: Amina.dd@ mail.ru

кандидат сельскохозяйственных наук, старший преподаватель
Контактная информация: Корпус: 1 (А), 213
Рабочий телефон: 21 19 79, 8702-480-49-48
Е-mail: Zhanar.@ mail.ru

Ерекбаева Акбопе Тонтаевна
Доктор PhD, старший преподаватель
Контактная информация: Корпус: 1 (А), 213
Рабочий телефон: 21 19 79 46-03-37, 87073733227
Е-mail: Адрес электронной почты защищен от спам-ботов. Для просмотра адреса в вашем браузере должен быть включен Javascript.

Магистр, преподаватель
Контактная информация: Корпус: 1 (А), 224
Рабочий телефон: 21 19 79, 87057009780
Е-mail: dariha_uko@ mail.ru

Доктор PhD, ассоциированный профессор
Контактная информация: Корпус: 1 (А), 217
Рабочий телефон: 21 19 79 46-03-37, 87016742491
Е-mail: Адрес электронной почты защищен от спам-ботов. Для просмотра адреса в вашем браузере должен быть включен Javascript.

Доктор биологических наук, профессор
Контактная информация: Рабочий телефон: 8(701)242-62-68
Е-mail: Адрес электронной почты защищен от спам-ботов. Для просмотра адреса в вашем браузере должен быть включен Javascript.

Кафедра биотехнологии Высшей школы “Химическая инженерия и Биотехнология” им.М. Ауэзова по итогам 2023 года по итогам конкурса “Лучший год-2023” награждена кафедрой биотехнологии в номинации “Лучшая КАФЕДРА-2023”. От всей души поздравляем коллег!!!
Научно-исследовательская работа и достижения кафедры

Шайдильда Жанжигит, студент группы ХТ-19-5к1, обсуждает научные работы







М.Әуезов атындағы ОҚУ «Химиялық инженерия және Биотехнология» жоғары мектебінің, “Биотехнология” кафедрасының доценті Бота Жақсылыққызы Муталиева Болашақ бағдарламасы бойынша “500 ғалымға” бөлінген грант иегері атанды. Әріптесімізді шын жүректен құттықтаймыз!!!



М.Әуезов атындағы ОҚУ, «Биотехнология» кафедрасының профессоры, ауылшаруашылығы ғылымының докторы Нурадин Алибаев ғылымды дамытудағы сүбелі еңбегінің арқасында “Ғылымды дамытудағы сіңірген еңбегі үшін” төсбелгісімен марапатталды. Құттықтаймыз!!!
М.Әуезов атындағы ОҚУ, «Биотехнология» кафедрасының доценті, ауылшаруашылығы ғылымының кандидаты Жанар Рахманбердиевна Елеманова, PhD Акбопе Тонтаевна Ермекбаева, магистр-оқытушы Дариха Ерадиловна Құдасова, Динара Нуралиевна Абдуллаева жастарды сапалы білім мен тәрбиелеудегі ерен еңбектері үшін марапатталды. Әріптестер, марапаттарыңыз құтты болсын!!!

Биотехнология кафедрасының оқытушысы, PhD, Туралиева Мөлдір Әлібекқызы 21-23 мамыр аралығында өткен “When cultures meet in Higher Education - new approaches in education” атты Халықаралық уоркшоп/семинарда спикер болып, “Biotechnology with STEM” атты тақырыпта лекция оқыды.
М.Әуезов атындағы ОҚУ, «Биотехнология» кафедрасының доценті, а/ш.ғ.к. Аханов Үсен Құдайбергенұлы ҚРҒЖБМ “ҒЫЛЫМДЫ ДАМЫТУҒА СІҢІРГЕН ЕҢБЕГІ ҮШІН” төс белгісімен марапатталды. Әріптесімізді шын жүректен құттықтаймыз!!!

2025-2026 ОҚУ ЖЫЛЫ: ҒЫЛЫМИ КЕҢЕСТІҢ АЛҒАШҚЫ ОТЫРЫСЫ ӨТТІ




НАГРАЖДЕНЫ ПОБЕДИТЕЛИ ПРЕДМЕТНОЙ ОЛИМПИАДЫ ПО ДИСЦИПЛИНЕ "БИОТЕХНОЛОГИЯ"
Абдезимов Жасулан , студент 2 курса Южно-Казахстанского университета им.М. Ауэзова, ОП биотехнологии, стал обладателем диплома 2-й степени (2-е место) по “биотехнологии” международной олимпиады на английском языке, набрав 275 баллов на 3 этапе олимпиады. Руководитель: заведующая кафедрой биотехнологии Алпамысова Гулжайна Байгонысовна. Жасулан молодец. Поздравляем!!!

Магистрант 2 курса Южно-Казахстанского университета им.М. Ауэзова Кожамуратов Едил стал обладателем диплома 1-й степени (1-е место) по “медицинской биологии” международной олимпиады, набрав 285 баллов на 3 этапе олимпиады. Руководитель: заведующая кафедрой биотехнологии Алпамысова Гулжайна Байгонысовна. Волга молодец. Поздравляем. Памятное фото с победителями сегодняшней Олимпиады!!!


XYII Республиканская предметная олимпиада по ОП 6В05102-Биотехнология, организованная МОН РК, прошла 21 апреля 2025 года в КазНУ им.Аль-Фараби. В олимпиаде приняли участие 23 из 11 вузов. Команда студентов 3 курса кафедры биотехнологии Южно-Казахстанского университета им.М. Ауэзова Амагельдиева Олжаса, Нуркиссаевны Айжанат, Уалихановой Сабины заняла III место. Руководитель: доцент Алпамысова Гулжайна байгонысовна и студентов-победителей поздравил председатель правления-ректор Южно-Казахстанского университета им.М. Ауэзова Д. Ахмед-Заки!!!







Для студентов группы ХТ-24-5к1 2 курса образовательной программы 6В05120 - Биотехнология наставником группым Ермекбаевой А.Т. был проведен час наставничества на тему: “8 сентября-пропаганда ежегодного Послания Президента Республики Казахстан Токаева К.Ж.”. В нынешнем Послании Президента были затронуты и всесторонне обсуждены актуальные вопросы страны. Со студентами группы были обсуждены основные приоритеты в Послании и рассмотрен вклад каждого гражданина в развитие государства.
Доктарант 1 курса кафедры биотехнологии Балхибеков Рахат Маратулы 27.02.25 года в 12.40 часов в аудитории 222 корпуса а прошел наставнический час на тему «Наркомания»,«Лудомания»!!!

ХТ-22-5-студенты группы К2 отметили час наставника в честь” Международного дня женщин и девочек в науке". На часе наставника Джалилов Ибрагим и Амангельдиев Олжас проявили активность и поделились многими подробностями, касающимися женщин, внесших свой вклад в науку. Кроме того, проблема современного дня, которая набирает обороты среди молодежи, была посвящена теме “наркомания - опасная болезнь общества и Лудомания”.
Уважаемые родители! По итогам осеннего семестра 2024-2025 учебного года он оказался в числе лучших студентов и показал себя требовательным и образованным человеком. Это, в первую очередь, плод вашей поддержки и воспитания. Поддержка родителей придаст ребенку уверенности, откроет путь к новым свершениям и поможет ему стать не только настоящим профессионалом своего дела, но и ответственным человеком. Выражаем Вам благодарность за вклад вашего ребенка в рейтинг образования нашей Высшей школы. Желаем вашей семье крепкого здоровья, большого счастья, неутомимого Кайрата, от всей души поздравляем обладателей наград со студентами ОП 6В05120-Биотехнология!!!
ХТ-22-5К2 тобының студенттері, топ тәлімгерімен бірге "Тәуелсіздік таңы мәңгілік!" атты тақырыпта тәлімгерлік сағатын өтті. Тәуелсіздік - бұл тек саяси құндылық ғана емес, ол біздің ұлттық бірлігіміз, мәдениетіміз бен тарихымыздың айқын көрінісі!
2024 жылдың 12-ші желтоқсан күні ХТ-22-5К1 тобының студенттері, топ тәлімгерімен бірге “Тәуелсіздік таңы мәңгілік!” атты тақырыпта тәлімгерлік сағатын өтті. Тәуелсіздік - бұл тек саяси құндылық ғана емес, ол біздің ұлттық бірлігіміз, мәдениетіміз бен тарихымыздың айқын көрінісі!
26.11.2024ж Биотехнология кафедрасының ХТ22-5-К2 тобының студенттері, топ тәлімгері кафедра доценті, PhD, М.А. Туралиевамен қоса Бейімбет Майлиннің 130 жыл туғанына орай “Бейімбет Майлин - кестелі ойдың шебері” және “Ұлт тарихындағы тұлға - Тұрар Рысқұловтың туғанына 130 жыл” атты тәлімгерлік сағатын атап өтті. Іс-шарада топ басшысы Дүйсенбек Алия белсенділік танытып, Ұлы тұлғалардың ерең еңбектеріне тереңірек тоқталды.
13 желтоқсан 2023 жылы Балхибеков Р.М., Елеманова Ж.Р. ХТ-21-5к1 тобында, Кудасова Д.Е., Ибраимова Ж.К. ХТ-22-5к1,2,5да, Аханов Ү.Қ., Кудасова Д.Е., Муталиева Б.Ж. ХТ-23-5к1,2,5р топтарында 25 қазан Республика күніне орай іс-шара өткізілді.
Білім күніне арналған академиялық топтарда тәрбие сағаттарын өткізу
М.Әуезов атындағы ОҚУ, «Биотехнология» кафедрасының 1 курс, ХТ-24-5к1 тобымен 10.09.2024 жылы «Мықты ұлт отбасында қалыптасады» тақырыбында тәлімгерлік сағаты өтті. Топ тәлімгері аға оқытушы, PhD А.Т. Ермекбаева және студенттер тәрбие сағаты барысында мықты ел болып қалыптасуымыздың басты себебі - отбасындағы қарым - қатынас екендігін нақтылай түсті. Отбасылық құндылықтарды дәріптеу арқылы керегесі мықты мемлекет қалыптастыратынымыз айғақ.
М.Әуезов атындағы ОҚУ, «Биотехнология» кафедрасының 2 курс ХТ-23-5а, ХТ-23-5дк топтарының студенттері қыркүйектің 2-ші жексенбісінің Отбасы күні аталып өткізуіне байланысты "Мықты ұлт отбасында қалыптасады" атты тәлімгерлік сағаты өтті.
М.Әуезов атындағы ОҚУ, «Биотехнология» кафедрасының студенттері 30.09.2024 ж. Еңбек күніне орай, “Менің жетістігім - менің нәтижем” атты тақырыпта ХТ-22-5К2 тобы, топ тәлімгері М.А.Туралиевамен бірге тәлімгерлік сағатын атап өтті. Тәлімгерлік сағат уоркшоп түрінде өтіп, студенттер жетістікке жету жолдарының алгоритмін жасады.
М.Әуезов атындағы ОҚУ, «Биотехнология» кафедрасының студенттері 03.09.2024 күні, ХТ-22-5-К2 тобы ҚР президенті Қ.К.Тоқаевтың 2024 жылғы жолдауын тәлімгерлік сағатында топ тәлімгері М.А. Туралиевамен талқылап шықты.
26 сәуір күні ХТ-22-да тобында «Әділетті Қазақстан.Адал азамат» атты тәлімгерлік сағат өтті. Тәрбие сағатында Мемлекет басшысы Қасым-Жомарт Тоқаевтың Ұлттық құрылтайда сөйлеген сөздері бойынша талқылау жасалды. Мемлекет басшысы Қасым-Жомарт Тоқаев өз сөзінде «Әділетті Қазақстан – Адал азамат» атты екінші отырысында сөйлеген сөзінде: Шын мәнінде, біз айтып жүрген Әділетті Қазақстанды Адал азаматтар құрады. Бұл – бір-бірімен өте тығыз байланысты ұғымдар. Отанға, отбасына адалдық – парасаттылық пен адамгершіліктің белгісі. Адал еңбек етіп, адал табыс тапқан адам жетістікке жетеді, құрметке ие болады. Ұлы Абай «Адал еңбекпен мал іздемек – арлы адамның ісі» деген. Ал арлы адам әділетсіздік жасамайды. Әр салада адалдық басты орында тұрса, әділ қоғам орнайды. Жемқорлыққа жол берілмейді, ел мүддесіне сай шешім қабылданады. Бір сөзбен айтсақ, қоғамдағы ізгіліктің бәрі адалдықтан бастау алады. Ендеше, Әділетті Қазақстан және Адал азамат ұғымдары ел тірегі болатын егіз құндылық ретінде әрдайым қатар тұруға тиіс.-деп атап өтті.
ХТ-22-5к2 тобының тәлімгері Балхибеков Рахат Маратұлы сағат 12.04.24 жылы сағат 14.00 де 120а аудиториясында «Әділетті Қазақстан.Адал адам» тақырыбында тәлімгерлік сағатын өтті.





М.Әуезов атында ОҚУ, Биотехнология БББ-ның 2-ші курс, ХТ-23-5Дк тобының студенті Нышанбай Аяулым Асқарқызы еңбекқор, ізденімпаздығымен көзге түсіп Аманат партиясының және Алтын Орда қоғамдық қорының ұйымдастыруымен Жастар Ресурстық Орталығында өткен жиында Е.Қажымның алғыс хатымен марапатталды. Жарайсың!!!
М.Әуезов атындағы ОҚУ, Биотехнология кафедрасының ПОҚ, студенттері “Қалалық сенбілікке” қатысып, таза қаламызға атсалысты!!!
М.Әуезов атындағы ОҚУ, Биотехнология кафедрасының ПОҚ ұйымдастыруымен Биотехнология БББ студенттерінің “Халықаралық студенттер“ мерекесіне арнап іс-шара өтті. Үздік, белсенді, полиглот студенттер мен үздік топтар және іс-шараға белсене араласқан студенттерде мерекелік сыйлықтармен марапатталды!!!
М.Әуезов атындағы ОҚУ, Биотехнология кафедрасының 1-ші курс студенттері ХТ-24-5к1,ХТ-24-5к2 тобының студенттері ұстаздар мерекесіне арнап “Ұстаз-ұлағатты тұлға” атты мерекелік іс-шараны жоғары деңгейде атап өтті. Жарайсыңдар!!!
М.Әуезов атындағы ОҚУ, «Биотехнология» кафедрасының 4-ші курс, ХТ-21-5к тобының студенттері «Тағам биотехнологиясы” пәнінен көкөністі биотехнологиялық жолмен кептіру жұмысын жасауда!!!
2024-2025 оқу жылында университеттің ішкі тәртіп ережелерімен, университетіміздегі студенттерге қажетті мүмкіндіктерді таныстыру қоғамдық жұмысқа белсенділігін арттыру мақсатында “Химиялық инженерия және Биотехнология” жоғары мектебінің ұйымдастыруымен 1-ші курс студенттерімен (10.09.2024) кездесу өтті.
2024-2025 оқу жылында университеттің ішкі тәртіп ережелерімен, университетіміздегі студенттерге қажетті мүмкіндіктерді таныстыру қоғамдық жұмысқа белсенділігін арттыру мақсатында “Химиялық инженерия және Биотехнология” жоғары мектебінің ұйымдастыруымен 1-ші курс студенттеріне (10.09.2024) “Студенттік мәселелер жөніндегі” департамент директоры А.А.Болысбек білімалушыларға көрсетілетін қызметі туралы түсіндірме жұмыстарын жүргізіп, қажетті ақпараттарды берді.
М. Әуезов атындағы ОҚУ, Биотехнология кафедрасы 2024-2025 оқу жылын жақсы жаңалықпен бастады. 2-ші курс ХТ-23-5а тобының студенті Абдезимов Жасұлан IELTS-8 балл жинап, жоғары нәтиже көрсетті.
М.Әуезов атындағы ОҚУ, Биотехнология мамандығының 2023-2024 оқу жылының бітіруші студенттері 2024 жыл 04.07 диплом алды. Құттықтаймыз, жарайсыңдар. Ақ жол!!!
М.Әуезов атындағы ОҚУ, Биотехнология мамандығының 2023-2024 оқу жылының бітіруші 4-ші курс студенттеріне қорытынды аттестаттау комиссиясының төрағасы мен мүшелері мемлекеттік емтиханды жақсы тапсырып шыққан түлектерге ақ жол тілеп, ізгі-тілек лебіздерін білдірді!!!!
М.Әуезов атындағы ОҚУ, Биотехнология мамандығының 2023-2024 оқу жылының бітіруші 4-ші курс студенттері дипломдық жұмыстарын жоғары деңгейде қорғап шықты. Жарайсыздар!!!!
26 сәуір күні ХТ-23-5к2 тобында «Әділетті Қазақстан.Адал азамат» атты тәлімгерлік сағат өтті. ХТ-23-5к2 тобының студенттері: Тойшы Маржан,Шамболат Дамира,Қожахметова Аружан,Темірхан Ақмарал,Бақытов Азат,Ахметов Санжар .Мемлекет басшысы Қасым-Жомарт Тоқаевтың Ұлттық құрылтайдың «Әділетті Қазақстан – Адал азамат» атты екінші отырысында сөйлеген сөзінде: Әділетті Қазақстанды құру үшін әрбір отандасымыз адал азамат болуға ұмтылуы қажет. Сонымен бірге жас ұрпақты адал азамат етіп тәрбиелеуіміз керек. Ұлттық бірегейлігімізді нығайтып, еліміздің жаңа құндылықтарын орнықтыру үшін жүйелі жұмыс жасалуға тиіс. Енді осы жұмыстың нақты бағыттарына тоқталды.














Приглашенный профессор из Государственного университетского колледжа Фейсалабада, доктор философии Махмуд-Ур-Рахман Ансари (Пакистан), прочитал лекцию студентам 3-го и 4-го курсов Южно-Казахстанского университета им. М. Ауэзова, факультета биотехнологии, и ответил на множество вопросов, возникших в связи с любопытством студентов!

Магистранты кафедры «Биотехнология» защитили магистерские диссертации на соискание ученой степени «Магистр наук» по образовательной программе 7М05123-«Биотехнология».
Магистранты 1 курса образовательной программы 7М05123-Биотехнология в соответствии с планом прохождения педагогической практики на базе кафедры с 03.02.2025 по 04.04.2025 магистрант группы МХТ-24 - 3нк Табанбаева Элеонора проводит лабораторное занятие по дисциплине "Лабораторное дело" в группе ХТ-24-5р. В ходе урока студентам были выполнены экспериментальные задания по организации исследовательской работы по видам химических лабораторных сосудов, особенностям их применения. Руководитель педагогической практики доцент Ермекбаева А.Т.

По программе академической мобильности кафедры «Биотехнология» магистранты и студенты обмениваются знаниями с зарубежными учебными заведениями. В рамках этой программы магистрантка 2 курса Калмаханова Арай проходит обучение на факультете биологии и охраны окружающей среды Лодзинского университета (г. Лодзь, Польша).
Магистранты 1 курса кафедры биотехнологии Южно-Казахстанского университета им. М. Ауэзова прошли стажировку в лаборатории биотехнологии Казахско-турецкого университета им. Х. А. Ясави с 06.05 по 17.05 2024 года!!!
Начата работа итоговой аттестационной комиссии магистрантов 2023-2024 учебного года специальности учеба, Биотехнология им. М. Ауэзова, удачи!!!
Магистрант группы МХТ-24(1)-3нк: Убайдулла Аружан Маратовна Научный руководитель: к. с.-х. н. доцент Алпамысова Г. Б.
Магистрант группы МХТ-24(1)-3нк: Кожамуратов Едил Жалгасулы Научный руководитель: к. с.-х. н. доцент Алпамысова Г. Б.
Магистрант группы МХТ-24(1)-3нк: Есенова Томирис Махсатовна Научный руководитель: к. с.-х. н. доцент Алпамысова Г. Б.
1 курс
Магистрант группы МХТ-23-3нк: Ербақ Актолкын Ерлановна Научный руководитель: к. с.-х. н. доцент Алпамысова Г. Б.
Магистрант группы МХТ-23-3нк: Кочкарова Дильноза Акмаловна Научный руководитель: к. с.-х. н. доцент Алпамысова Г. Б.
Магистрант группы МХТ-23-3нк: Шкурова Нурасел Асанжановна Научный руководитель: к. с.-х. н. доцент Алпамысова Г. Б.
Магистрант группы МХТ-23-3нк: Кинжигит Аружан Сабитовна Научный руководитель: к. с.-х. н. доцент Алпамысова Г. Б.
2 курс
Магистрант группы МХТ-22-3нк: Абдрахманова Дина Абдуллаевна Научный руководитель: д. с. х. н.профессор Алибаев Н. Н.
Магистрант группы МХТ-22-3нк: Бердикулова Меруерт Нургалымовна Научный руководитель: к. х. н., ассоциированный.профессор Муталиева Б. Ж.
Магистрант группы МХТ-22-3нк: Жаннигитова Акерке Научный руководитель: д. т. н. профессор Кедельбаев Б. Ш.
Магистрант группы МХТ-22 - 3нк: Зулкайнар Сырлыбай Саттарович Научный руководитель: к. х. н., ассоциированный.профессор Муталиева Б. Ж.
Магистрант группы МХТ-22-3нк: Исмаил Зульфия Мансуровна Научный руководитель: к. б.н.профессор Сапарбекова А. А.
Магистрант группы МХТ-22-3нк: Кали Улдана Мамырхановна Научный руководитель: д. с. х. н.профессор Алибаев Н. Н.
Магистрант группы МХТ-22-3нк: Калыбай Акжаркын Бекеновна Научный руководитель: д. б.н.профессор Исаева А. У.
Магистрант группы МХТ-22-3нк: Лесбекова Дана Маратовна Научный руководитель: к. х. н., ассоциированный.профессор Муталиева Б. Ж.
Магистрант группы МХТ-22 - 3нк: Альгаппар Максат Батыржанович Научный руководитель: к. б.н., доцент Рысбаева Г.
Магистрант группы МХТ-22-3нк: Турманова Жанбота Сакеновна Научный руководитель: к. х. н., ассоциированный.профессор Муталиева Б. Ж.
Магистрант группы МХТ-22 - 3нк: Сабитбек Толеби Касмуханович Научный руководитель: к. б.н., доцент Рысбаева Г.
Магистрант группы МХТ-22-3нк: Шертаева Алида Ертаевна Научный руководитель: к. б.н., доцент Рысбаева Г.
Магистрант группы МХТ-22-3нк: Болысбек Оразкул Курманбетовна Научный руководитель: д. с.-х. н., профессор Алибаев Н. Н.
Магистрант группы МХТ-22-3нк: Батыржан Акжаик Ерлановна Научный руководитель: д. с.-х. н., профессор Алибаев Н. Н.
Магистрант группы МХТ-22-3нк: Куланбай Фариза Ерболовна Научный руководитель: к. б.н., профессор Сапарбекова А. А.
Магистрант группы МХТ-22-3нк: Бижигит Богенбайжигитович Научный руководитель: к. б.н., профессор Сапарбекова А. А.
Магистрант группы МХТ-22-3нк: Абдрейм Шахризада Сериковна Научный руководитель: к. б.н., доцент Рысбаева Г.
Магистрант группы МХТ-22-3нк: Медетовна Аружан Научный руководитель: к. б.н., доцент Рысбаева Г.
Магистрант группы МХТ-22-3нк: Бегалы Аксезим Ералықызы Научный руководитель: д. б.н., профессор Исаева А. У.
Магистрант группы МХТ-22-3нк: Бердахметова Алмас Нургалиевна Научный руководитель: д. б.н., профессор Исаева А. У.
2 курс
Магистрант группы МХТ-22-3на: Жибек Армановна Научный руководитель: к. б.н., профессор Сапарбекова А. А.
Магистрант группы МХТ-22-3На: Есимкулова Айымжан Абдиганиевна Научный руководитель: к. б.н., профессор Сапарбекова А. А.
Магистрант группы МХТ-22-3на: Сайдазова Лобар Ахмаджановна Научный руководитель: к. б.н., профессор Сапарбекова А. А.
2 курс
Магистрант группы МХТ-22(1)-3нк: Толеген Нуркызай Каныбековна Научный руководитель: PhD, преподаватель Туралиева М.
На стажировку пришли магистранты 2 курса ОП по биологии МКТУ им. К. Ясави!!!
Студенты магистратуры кафедры биотехнологии Южно-Казахстанского университета имени М.Ауэзова проходят стажировку!!!



М. Әуезов атындағы Биотехнология кафедрасының 2-ші курс докторанты Қалдыбекова Гүлнұр шетелдік кеңесшісінің басшылығымен Хорватия елі, Загреб университетінің профессоры Марко Винцековичпен 2024 жылдың 27.05-27.06 аралығында тағылымдамадан өтуде.
М. Әуезов атындағы Биотехнология кафедрасының 2-ші курс докторанты Оспанова Айкерім шетелдік кеңесшісінің басшылығымен Хорватия елі, Загреб университетінің профессоры Марко Винцековичпен 2024 жылдың 27.05-27.06 аралығында тағылымдамадан өтуде.
М. Әуезов атындағы Биотехнология кафедрасының 1-ші курс докторанты Сайдуллаева Лейланың шетелдік кеңесшісінің басшылығымен Хорватия елі, Загреб университетінің профессоры Марко Винцековичпен 2024 жылдың 27.05-27.06 аралығында тағылымдамадан өтуде.
М. Әуезов атындағы Биотехнология кафедрасының 1, 2-ші курс докторанттары Оспанова Айкерім, Қалдыбекова Гүлнұр, Тамила, Сайдуллаева Лейланың шетелдік кеңесшісінің басшылығымен Хорватия елі, Загреб университетінің профессоры Марко Винцековичпен 2024 жылдың 27.05-27.06 аралығында тағылымдамадан өтуде. Сәттілік!!!
М.Әуезов атындағы ОҚУ, “Биотехнология” кафедрасының 2 курс докторанты Алихан Акмарал 1 мамыр-Қазақстан халықтарының бірлігі мерекесіне, 1 курс ХТ-23-5к2 тобына «Ынтымақ, бірлік, келісім – ең басты байлық ел үшін» атты ашық-тәрбие сағатын өтті. Мереке қарсаңында өткізіліп отырған ашық-тәрбие сағаттың мақсаты: Халықтар арасындағы ынтымақ, бірлік, достықты нығайту, осы мақсатта студенттердің достық қарым-қатынастарын қалыптастыруды жалғастыру. Қазақстанның өркендеуіне ынтымақ, бірлік, келісім арқылы өз үлестерін қосуға студенттерді баулу. Қазақ халқы сырттан келген басқа ұлт өкілдеріне алтын бесік болғандығын ұғындыру. Студенттерді патриотизмге, елін, жерін сүюге және халқын құрметтеуге тәрбиелеу. Басқа ұлт өкілдерінің мәдениетін, әдет-ғұрпын сыйлауға үйрету. 1-мамыр Қазақстан халықының бірлігі күні екенін студенттерге жеткізу. Ынтымақтыққа, достыққа, өз Отанын сүюге, қорғауға тәрбиелеу. Ел ішіндегі түрлі ұлт өкілдерінің бір - біріне деген сый - құрметін арттырып, татулықты, бірлікті, ортақ құндылықтарды насихаттау. Халықтар арасындағы достықты нығайту.
М.Әуезов атындағы ОҚУ, «Биотехнология» кафедрасының 2 курс докторанты Алихан Акмарал Польша елі, Познань қаласы «Poznan University of Life Sciences» университетіндегі ғылыми-зерттеу жұмысының нәтижесі бойынша тағылымдаманың есебін берді.





М. Әуезов атындағы Биотехнология кафедрасының докторанттары Тамила, Сайд Хорватия елі, Загреб университетінде тағылымдамадан өтіп, ғылыми-зерттеу жұмыстарының нәтижесі бойынша конференцияда баяндама жасауда, сәттілік!!!
М.Әуезов атындағы ОҚУ, “8D05120-Агроөнеркәсіп саласындағы биотехнологиялық аспектілер” БББ-ның 1-ші курс докторанттары педагогикалық практикасы бойынша есеп берді!!!
М.Әуезов атындағы ОҚУ, Биотехнология БББ-ның 1-ші курс докторанты Сайдуллаева Лайла педагогикалық практикада. 04.04.2024ж. МХТ-23-3нк тобына “Биомассаны алу және өңдеудің биотехнологиясы” пәнінен “Биомассаны анықтау және бөліп алу әдісін зерттеу” тақырыбы бойынша ашық сабақ жүргізді.
Анализ предстоящей работы был проведен совместно с иностранным научным руководителем докторантов кафедры биотехнологии Южно-Казахстанского университета имени М. Ауэзова, кандидатом наук Махмудом-Ур-Рахманом Ансари (Пакистан), ученым, приглашенным в качестве приглашенного профессора из Государственного университетского колледжа Фейсалабада!!!



Жаймбаева Камшат Жасымбекқызы
Адильбекова Эльмира Калыбаевна
Доктор PhD, старший преподаватель кафедры «Микробиология и биотехнология» Казахского агротехнического исследовательского университета им.С. Сейфуллина. Выпускник 2014 года.
Әбутәліп Бауыржан
ТОО "Инновационный комплекс Састобе", Оператор.
Выпускник 2020 года.
Ахмет Салтанат Нұрғалиқызы
Выпускница 2024 года ОП 6В05120-Биотехнология Южно-Казахстанского университета им.М. Ауэзова Ахмет Салтанат Нургалиевна работает главным специалистом в лаборатории химического талтау “Петро Казахстан Ойл Продактста”.
Нышан Меруерт
Әскербек Аяна
Выпускник ОП 6В05120-Биотехнология Южно-Казахстанского университета им.М.Ауэзова 2024 года, Аскербек Аяна главный специалист по обслуживанию.
Узденбаева Айман
Выпускница Южно-Казахстанского университета им. М. Ауэзова 6B05120-ОП Биотехнология 2024 года, Узденбаева Айман работает лаборантом в лаборатории in-vivo г. Шымкент.
6В05120 - по ОП "Биотехнология"
БАЗА ПРАКТИКИ
1. Отдел лабораторно-аналитического контроля департамента экологии по городу Шымкент
2. ТОО "Бал Текстиль" г.Шымкент
3. ТОО "Компания Фуд Мастер-Шымкент" Туркестанская область, Толебийский район, село Коксаек,
4. ТОО "Шымкент құс" г.Шымкент
5. Консервный завод «Глобус», Шымкент
6. LOTTE-Рахат ТОО, Шымкент





М.Әуезов атындағы ОҚУ, Биотехнология кафедрасының 3-ші курс студенттері 27.01-21.02.2025 жыл аралығында Шымкент қаласындағы М.Маметова атындағы N35 ЖОМ педагогикалық практикадан өтуде!!!
М.Әуезов атындағы ОҚУ, Биотехнология кафедрасының 3-ші курс студенттері 27.01-21.02.2025 жыл аралығында Шымкент қаласындағы М.Горький атындағы N12 ЖОМ, педагогикалық практикадан өттілуде!!!
М.Әуезов атындағы ОҚУ, Биотехнология кафедрасының 2-ші курс студенттері 27.01-21.02.2025 жыл аралығында Сайрам аудандық ауруханасы зертханасында жүргізіліп жатқан іс-тәжірибе!!!
М.Әуезов атындағы ОҚУ, Биотехнология кафедрасының базасында практикадан өту үшін Қ.А.Ясауи атындағы ХҚТУ-нің ғылыми Биология, Биотехнология БББ, 4 курс студенттері лабораторияда зерттеу жұмыстарын жүргізуде!!!

М.Әуезов атындағы ОҚУ, Биотехнология кафедрасының 2-ші курс, ХТ-23-5р тобының студенті Халикулова Карина 27.01-21.02.2025 жыл аралығында Шымкент қаласындағы “Alem Su” ЖШС 4 апталық өндірістік практикадан өтуде!!!

М.Әуезов атындағы ОҚУ, Биотехнология кафедрасының 2-ші курс, ХТ-23-5р тобының студенті Музириддинова Санобар коагулограмма аппаратымен танысып және оны тәжірибеде қолданданып, қанның ұю қабілетін бағалады.
М.Әуезов атындағы ОҚУ, Биотехнология кафедрасының 2-ші курс студенттері 27.01-21.02.2025 жыл аралығында Шымкент қаласындағы “Рахат-Шымкент” ЖШС 4 апталық өндірістік практикадан өтуде!!!
М.Әуезов атындағы ОҚУ, Биотехнология кафедрасының базасында практикадан өту үшін Қ.А.Ясауи атындағы ХҚТУ-нің ғылыми Биология, Биотехнология БББ, 4 курс студенттері лабораторияда зерттеу жұмыстарын жүргізуде!!!
М.Әуезов атындағы ОҚУ, Биотехнология кафедрасының 2-ші курс студенттері 27.01-21.02.2025 жыл аралығында Шымкент қаласындағы “Фуд-Мастер” ЖШС 4 апталық өндірістік практикадан өтуде!!!
М.Әуезов атындағы ОҚУ, Биотехнология кафедрасының 2-ші курс студенттері 27.01-21.02.2025 жыл аралығында Шымкент қаласындағы “Рахат” ЖШС 4 апталық өндірістік практикадан өтуде!!!
М.Әуезов атындағы ОҚУ, Биотехнология кафедрасының базасында практикадан өту үшін Қ.А.Ясауи атындағы ХҚТУ-нің ғылыми Биология, Биотехнология БББ, 4 курс студенттері университеттің базасымен танысты!!!
М.Әуезов атындағы ОҚУ, Биотехнология кафедрасының 2-ші курс студенттері 27.01-21.02.2025 жыл аралығында Шымкент қаласындағы “Рахат-Шымкент” ЖШС, “Эм-Нұр” ЖШС, “Алем-су” ЖШС, “Клиенс-Фабрик” ЖШС, Ақтөбе қаласындағы “Айс-плюс”ЖШС 4 апталық өндірістік практикадан өтуде!!!
М.Әуезов атындағы ОҚУ, Биотехнология кафедрасының 2-ші курс студенттері 27.01-21.02.2025 жыл аралығында Шымкент қаласындағы “Рахат-Шымкент” ЖШС, “Эм-Нұр” ЖШС, “Алем-су” ЖШС, “Клиенс-Фабрик” ЖШС, Ақтөбе қаласындағы “Айс-плюс”ЖШС 4 апталық өндірістік практикадан өтуде!!!
М.Әуезов атындағы ОҚУ, «Биотехнология» кафедрасының 4-ші курс, ХТ-21-5к тобының студенттері өндірістік практиканың есебін тапсырды!!!
М.Әуезов атындағы ОҚУ, «Биотехнология» кафедрасының 3-ші курс, ХТ-22-5к2 тобының студенттері өндірістік практиканың есебін тапсырды!!!
М.Әуезов атындағы ОҚУ, «Биотехнология» кафедрасының 3-ші курс, ХТ-22-5да тобының студенттері өндірістік практиканың есебін тапсырды!!!
М.Әуезов атындағы ОҚУ, «Биотехнология» кафедрасының 3-ші курс, ХТ-22-5к1 тобының студенттері өндірістік практиканың есебін тапсырды!!!
М.Әуезов атындағы ОҚУ, «Биотехнология» кафедрасының 2-ші курс студенттері Өзбекстан Республикасы, Ташкент химия-технологиялық институтында 1 апталық практикадан өтуде, практика барысында Микробиология институтының лабораториясында жүргізіліп жатқан жұмыстармен таныстырды!!!
М.Әуезов атындағы ОҚУ, «Биотехнология» кафедрасының 2-ші курс студенттері Өзбекстан Республикасы, Ташкент химия-технологиялық институтында 1 апталық практикадан өтуде, практика барысында Бейорганикалық химия институтының лабораториясында in-vitro жағдайында өсімдіктерді өсіру, қоректік ортаны дайындау бойынша жұмыстармен таныстырды!!!
М.Әуезов атындағы ОҚУ, «Биотехнология» кафедрасының 1-ші курс студенттері Өзбекстан Республикасы, Ташкент химия-технологиялық институтында 1 апталық практикадан өтуде!!!
М.Әуезов атындағы ОҚУ, «Биотехнология» кафедрасының 2-ші курс студенттері ФудМастерде 4 апталық практикадан өтуде!
М.Әуезов атындағы ОҚУ, «Биотехнология» кафедрасының 2-ші курс студенттері ФудМастерде 4 апталық практикадан өтуде!
М. Әуезов атындағы ОҚУ “Химиялық инженерия және Биотехнология” жоғары мектебі, Биотехнология кафедрасы, 4-курс студенттері дипломалды практика барысында өндірістерде ғылыми-зерттеу жұмыстарын жүргізуде.
М.Әуезов атындағы ОҚУ, Биотехнология кафедрасының дайындайтын 6В05120-Биотехнология БББ 3-ші курс студенттері 4 апталық өндірістік ll практика барысында берілген жеке тапсырмалары бойынша есебін тапсырды!!!

Студенты 2 курса ОП 6В05120 - Биотехнология, готовящиеся кафедрой биотехнологии Южно-Казахстанского университета им. М.Ауэзова, проводят 3 - недельную производственную практику в “Берте-Милке”!!!




-
профессор Ван Азлина Ван Аб Карим Гани,
-
профессор Хасфалина Бинти Че Ман,
-
ассоциированный профессор Норхашила Бинти Хашим,
-
доктор PhD Сити Изера Бинти Исмаил,
М.Әуезов атындағы ОҚУ, «Биотехнология» кафедрасының доценті Б.Ж. Муталиева ҚРҒЖБМ қаржыландыратын “Болашақтың 500 ғалымы” бағдарламасымен ғылыми тағылымдамадан өтуіне байланысты 23.09.2024-29.06.2025 аралығында Ұлыбритания елінде. Тағылымдаманың жұмысы басталып кетті!!!
Кафедра биотехнологии Южно-Казахстанского университета им. М.Ауэзова начала свою работу с заведующей кафедрой биотехнологии, профессором Луной Масловой из Загребского университета (Хорватия), с 3 по 9 сентября в рамках программы внешней академической мобильности на 2023-2024 учебный год!!!
В рамках программы внешней академической мобильности на 2023-2024 учебный год кафедра биотехнологии Южно-Казахстанского университета им. М. Ауэзова ознакомила сегодня с научной работой, проводимой в нашем университете!






М.Әуезов атындағы ОҚУ, Биотехнология кафедрасымен Өзбекстан Республикасы, Ташкент қаласындағы Мирзо Улугбек атындағы Ұлттық университетінің Биотехнология кафедрасы ПОҚ университетіміздің материалдық базасымен танысты!!!
Академиялық ұтқырлық мақсатымен Қарақалпақ мемлекеттік университетінде

М. Әуезов атындағы Оңтүстік Қазақстан университеті, Биотехнология кафедрасының ПОҚ Қоқан мемлекеттік педагогикалық институтындағы 2024 жылдың 20.05-24.05 аралығында жоспарланған сыртқы академиялық ұтқырлықтың соңғы күніндегі кафедрадағы отырыс!!!
М. Әуезов атындағы Оңтүстік Қазақстан университеті, Биотехнология кафедрасының доценті Г.Б.Алпамысова Қоқан мемлекеттік педагогикалық институтында 2024 жылдың 20.05-24.05 аралығында сыртқы академиялық ұтқырлық бағдарламасымен лекция жүргізуде!!!
М. Әуезов атындағы Оңтүстік Қазақстан университеті, Биотехнология кафедрасының профессоры Б.Ж.Муталиева Кокан мемлекеттік педагогикалық институтында 2024 жылдың 20.05-24.05 аралығында сыртқы академиялық ұтқырлық бағдарламасымен лекция жүргізуде!!!
М. Әуезов атындағы Оңтүстік Қазақстан университеті, Биотехнология кафедрасының профессоры Б.Ж.Муталиева Қоқан мемлекеттік педагогикалық институтында өткен халықаралық конференцияда баяндама жасады!!!
М. Әуезов атындағы Биотехнология кафедрасының ПОҚ Кокан мемлекеттік педагогикалық институтында 2024 жылдың 20.05-24.05 аралығында сыртқы академиялық ұтқырлық бағдарламасымен барып, институт базасымен танысты!!!


Сондай-ақ, Загреб университеті факультеті деканының орынбасарымен университеттер арасындағы одан әрі зерттеулер мен ынтымақтастық туралы кездесу ұйымдастырылды. Осылайша, Загреб Университетіне ғылыми іссапар жоспарланған жұмыстарға сәйкес жүргізілді.
Сондай-ақ, Загреб университеті факультеті деканының орынбасарымен университеттер арасындағы одан әрі зерттеулер мен ынтымақтастық туралы кездесу ұйымдастырылды. Осылайша, Загреб Университетіне ғылыми іссапар жоспарланған жұмыстарға сәйкес жүргізілді.
М. Әуезов атындағы ОҚУ, Биотехнология кафедрасына сыртқы академиялық ұтқырлық бағдарламасымен Самарканд мемлекеттік техникалық университетінің ғалымдары 04.12-10.12.2023 аралығында дәріс жүргізді!!!
1. Микрокапсулирование как новый тип удобрений.






Начата работа «Летней школы» (29.05-10.06.2024 год), организованная кафедрой “Биотехнология”, учебной кафедрой им.М. Ауэзова. В Летней школе д. б.н., профессор кафедры” Микробиологии и биотехнологии " Шохиста Ташмухамедова (НУУз им. Мирзо Улугбек, РУз) провел лекцию “Новые подходы в иммуноферментном анализе“. Ученый поднял самые основные актуальные проблемы, много информации о сложных вопросах развития науки, летняя школа проходит интересно!!!
Начата работа «Летней школы» (29.05-10.06.2024 год), организованная кафедрой “Биотехнология”, учебной кафедрой им.М. Ауэзова. В Летней школе к. х. н., доцент Каримова Диловар (Кокандский государственный педагогический институт им. Мукими) провела лекцию“ Развитие товарной химии в Узбекистане". Ученый поднял самые основные актуальные проблемы, много информации о сложных вопросах развития науки, летняя школа проходит интересно!!!
Начата работа «Летней школы» (29.05-10.06.2024 год), организованная кафедрой “Биотехнология”, учебной кафедрой им.М. Ауэзова. В Летней школе PhD, доцент Тастамбек Куаныш (постдокторант научно-исследовательского университета им.М. Ауэзова, главный научный сотрудник Научно-исследовательского института экологии) провел лекцию “Hydrogenotrophic methanogenesis in coal-bearing environments: Methane production, carbon sequestration, and hydrogen availability“. Ученый поднял самые основные актуальные проблемы, много информации о сложных вопросах развития науки, летняя школа проходит интересно!!!
Начата работа «Летней школы» (29.05-10.06.2024 год), организованная кафедрой “Биотехнология”, учебной кафедрой им.М. Ауэзова. В Летней школе проводятся лекции дальних и ближних зарубежных ученых об устойчивом развитии и зеленой экономике, значении международных связей в организации проектов.







Председатель диссертационного совета:
Алпамысова Гульжайна Байконысовна
Кандидат сельскохозяйственных наук, доцент
Контактная информация: Корпус: 1 (А), 215
Рабочий телефон: 8 (7252) 21-19-79, 87712489338
E-mail: Адрес электронной почты защищен от спам-ботов. Для просмотра адреса в вашем браузере должен быть включен Javascript.
Член диссертационного совета:
Алибаев Нуридин Нажмединович
Доктор сельскохозяйственных наук, профессор
Контактная информация: Корпус: 1 (А), 315
Рабочий телефон: 21 19 79, 87017203237
E-mail: Адрес электронной почты защищен от спам-ботов. Для просмотра адреса в вашем браузере должен быть включен Javascript.
Заместитель председателя диссертационного совета
Жамбакин Кабыл Жапарович
Доктор биологических наук, профессор
Контактная информация:
Рабочий телефон:
E-mail:
Секретарь диссертационного совета:
Сапарбекова Альмира Амангельдиевна
Кандидат биологических наук, профессор
Контактная информация: Корпус: 1 (А), 224
Рабочий телефон: 8 (7252) 21-19-79, 95-32-68, 87054907555
E-mail: Адрес электронной почты защищен от спам-ботов. Для просмотра адреса в вашем браузере должен быть включен Javascript.
01.12.2023. Защита PhD диссертации Тлеукеевой Асель Ержановны. Научные консультанты: профессора Алибаев Н.Н., Жамбакин К., Панкиевич Р( Польша). Официальные рецензенты: проф. Науанова А.П. (Агроунивер имени С. Сейфуллина, Астана), Анарбекова Г. (КазНПУ, Алматы). В качестве временных членов диссовета приглашены проф. Курманбаев А.А.( Алматы), Мукашева Т.Д. ( Алматы), Ибадуллаева С.Ж. (Кызыл-Орда), Табиаш Л.(Познань). ВрИО Председателя диссовета: Абсадикова Ш.Н. (Алматы), Уч.Секретарь: Сапарбекова А.А. Тема диссертации “Разработка альгоудобрения на основе процессов комплексной конверсии фосфорсодержащих отходов г.Шымкент”.